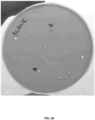
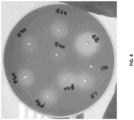
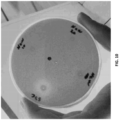

EP3607097B1 - Bacillus host cells producing beta-galactosidases and lactases in the absence of p-nitrobenzylesterase side activity - Google Patents
Bacillus host cells producing beta-galactosidases and lactases in the absence of p-nitrobenzylesterase side activity Download PDFInfo
- Publication number
- EP3607097B1 EP3607097B1 EP18720841.8A EP18720841A EP3607097B1 EP 3607097 B1 EP3607097 B1 EP 3607097B1 EP 18720841 A EP18720841 A EP 18720841A EP 3607097 B1 EP3607097 B1 EP 3607097B1
- Authority
- EP
- European Patent Office
- Prior art keywords
- polypeptide
- activity
- seq
- nbe
- host cell
- Prior art date
- Legal status (The legal status is an assumption and is not a legal conclusion. Google has not performed a legal analysis and makes no representation as to the accuracy of the status listed.)
- Active
Links
Images
Classifications
-
- C—CHEMISTRY; METALLURGY
- C12—BIOCHEMISTRY; BEER; SPIRITS; WINE; VINEGAR; MICROBIOLOGY; ENZYMOLOGY; MUTATION OR GENETIC ENGINEERING
- C12N—MICROORGANISMS OR ENZYMES; COMPOSITIONS THEREOF; PROPAGATING, PRESERVING, OR MAINTAINING MICROORGANISMS; MUTATION OR GENETIC ENGINEERING; CULTURE MEDIA
- C12N9/00—Enzymes; Proenzymes; Compositions thereof; Processes for preparing, activating, inhibiting, separating or purifying enzymes
- C12N9/14—Hydrolases (3)
- C12N9/24—Hydrolases (3) acting on glycosyl compounds (3.2)
- C12N9/2402—Hydrolases (3) acting on glycosyl compounds (3.2) hydrolysing O- and S- glycosyl compounds (3.2.1)
- C12N9/2468—Hydrolases (3) acting on glycosyl compounds (3.2) hydrolysing O- and S- glycosyl compounds (3.2.1) acting on beta-galactose-glycoside bonds, e.g. carrageenases (3.2.1.83; 3.2.1.157); beta-agarase (3.2.1.81)
- C12N9/2471—Beta-galactosidase (3.2.1.23), i.e. exo-(1-->4)-beta-D-galactanase
-
- C—CHEMISTRY; METALLURGY
- C12—BIOCHEMISTRY; BEER; SPIRITS; WINE; VINEGAR; MICROBIOLOGY; ENZYMOLOGY; MUTATION OR GENETIC ENGINEERING
- C12P—FERMENTATION OR ENZYME-USING PROCESSES TO SYNTHESISE A DESIRED CHEMICAL COMPOUND OR COMPOSITION OR TO SEPARATE OPTICAL ISOMERS FROM A RACEMIC MIXTURE
- C12P21/00—Preparation of peptides or proteins
- C12P21/02—Preparation of peptides or proteins having a known sequence of two or more amino acids, e.g. glutathione
-
- A—HUMAN NECESSITIES
- A23—FOODS OR FOODSTUFFS; TREATMENT THEREOF, NOT COVERED BY OTHER CLASSES
- A23C—DAIRY PRODUCTS, e.g. MILK, BUTTER OR CHEESE; MILK OR CHEESE SUBSTITUTES; PREPARATION THEREOF
- A23C9/00—Milk preparations; Milk powder or milk powder preparations
- A23C9/12—Fermented milk preparations; Treatment using microorganisms or enzymes
- A23C9/1203—Addition of, or treatment with, enzymes or microorganisms other than lactobacteriaceae
- A23C9/1206—Lactose hydrolysing enzymes, e.g. lactase, beta-galactosidase
-
- C—CHEMISTRY; METALLURGY
- C12—BIOCHEMISTRY; BEER; SPIRITS; WINE; VINEGAR; MICROBIOLOGY; ENZYMOLOGY; MUTATION OR GENETIC ENGINEERING
- C12N—MICROORGANISMS OR ENZYMES; COMPOSITIONS THEREOF; PROPAGATING, PRESERVING, OR MAINTAINING MICROORGANISMS; MUTATION OR GENETIC ENGINEERING; CULTURE MEDIA
- C12N1/00—Microorganisms; Compositions thereof; Processes of propagating, maintaining or preserving microorganisms or compositions thereof; Processes of preparing or isolating a composition containing a microorganism; Culture media therefor
- C12N1/20—Bacteria; Culture media therefor
-
- C—CHEMISTRY; METALLURGY
- C12—BIOCHEMISTRY; BEER; SPIRITS; WINE; VINEGAR; MICROBIOLOGY; ENZYMOLOGY; MUTATION OR GENETIC ENGINEERING
- C12N—MICROORGANISMS OR ENZYMES; COMPOSITIONS THEREOF; PROPAGATING, PRESERVING, OR MAINTAINING MICROORGANISMS; MUTATION OR GENETIC ENGINEERING; CULTURE MEDIA
- C12N15/00—Mutation or genetic engineering; DNA or RNA concerning genetic engineering, vectors, e.g. plasmids, or their isolation, preparation or purification; Use of hosts therefor
- C12N15/09—Recombinant DNA-technology
- C12N15/63—Introduction of foreign genetic material using vectors; Vectors; Use of hosts therefor; Regulation of expression
- C12N15/74—Vectors or expression systems specially adapted for prokaryotic hosts other than E. coli, e.g. Lactobacillus, Micromonospora
- C12N15/75—Vectors or expression systems specially adapted for prokaryotic hosts other than E. coli, e.g. Lactobacillus, Micromonospora for Bacillus
-
- C—CHEMISTRY; METALLURGY
- C12—BIOCHEMISTRY; BEER; SPIRITS; WINE; VINEGAR; MICROBIOLOGY; ENZYMOLOGY; MUTATION OR GENETIC ENGINEERING
- C12Y—ENZYMES
- C12Y302/00—Hydrolases acting on glycosyl compounds, i.e. glycosylases (3.2)
- C12Y302/01—Glycosidases, i.e. enzymes hydrolysing O- and S-glycosyl compounds (3.2.1)
- C12Y302/01023—Beta-galactosidase (3.2.1.23), i.e. exo-(1-->4)-beta-D-galactanase
-
- C—CHEMISTRY; METALLURGY
- C12—BIOCHEMISTRY; BEER; SPIRITS; WINE; VINEGAR; MICROBIOLOGY; ENZYMOLOGY; MUTATION OR GENETIC ENGINEERING
- C12N—MICROORGANISMS OR ENZYMES; COMPOSITIONS THEREOF; PROPAGATING, PRESERVING, OR MAINTAINING MICROORGANISMS; MUTATION OR GENETIC ENGINEERING; CULTURE MEDIA
- C12N2510/00—Genetically modified cells
-
- C—CHEMISTRY; METALLURGY
- C12—BIOCHEMISTRY; BEER; SPIRITS; WINE; VINEGAR; MICROBIOLOGY; ENZYMOLOGY; MUTATION OR GENETIC ENGINEERING
- C12N—MICROORGANISMS OR ENZYMES; COMPOSITIONS THEREOF; PROPAGATING, PRESERVING, OR MAINTAINING MICROORGANISMS; MUTATION OR GENETIC ENGINEERING; CULTURE MEDIA
- C12N9/00—Enzymes; Proenzymes; Compositions thereof; Processes for preparing, activating, inhibiting, separating or purifying enzymes
- C12N9/14—Hydrolases (3)
- C12N9/16—Hydrolases (3) acting on ester bonds (3.1)
- C12N9/18—Carboxylic ester hydrolases (3.1.1)
-
- C—CHEMISTRY; METALLURGY
- C12—BIOCHEMISTRY; BEER; SPIRITS; WINE; VINEGAR; MICROBIOLOGY; ENZYMOLOGY; MUTATION OR GENETIC ENGINEERING
- C12Y—ENZYMES
- C12Y301/00—Hydrolases acting on ester bonds (3.1)
- C12Y301/01—Carboxylic ester hydrolases (3.1.1)
Definitions
- the present disclosure is generally related to the fields of bacteriology, microbiology, genetics, molecular biology, enzymology, probiotics, dairy food products and the like. Certain embodiments of the disclosure are directed to genetically modified Bacillus host cells expressing/producing ⁇ -galactosidase and/or lactase enzymes.
- certain embodiments are directed to expressing/producing such ⁇ -galactosidase and/or lactase enzymes in modified Bacillus host cells, wherein such enzymes produced and purified from the modified Bacillus host cells are free of unwanted/undesirable enzymatic side activities including, but not limited to, unwanted/undesirable lipase side activities, phospholipase side activities, cellulase side activities, pectinase side activities, amylase side activities, protease side activities, mannanase side activities and the like.
- galactooligosaccharides are carbohydrates which are non-digestible in humans (and animals), comprising two or more galactose molecules (typically up to nine) linked by glycosidic bonds.
- a particularly beneficial effect of such galactooligosaccharides is their ability to act as pre-biotic compounds, by selectively stimulating the proliferation of beneficial (colonic) microorganisms (e.g ., bacteria) that provide physiological benefits to the consumer of such GOS compositions.
- beneficial microorganisms e.g ., bacteria
- the enzyme ⁇ -galactosidase (EC 3.2.1.23) generally hydrolyzes lactose to the monosaccharides D-glucose and D-galactose.
- the enzyme hydrolyzes lactose and transiently binds the galactose monosaccharide in a galactose-enzyme complex.
- water is used to hydrolyze the covalent galactose-enzyme intermediate, thereby resulting in the liberation of D-galactose and D-glucose.
- the genus Bifidobacterium is commonly used in the dairy industry, wherein the ingestion of Bifidobacterium-containing products furthermore has a health-promoting effect. This effect is not only achieved by a lowered pH of the intestinal contents, but also by the ability of Bifidobacterium to repopulate the intestinal flora in individuals who have had their intestinal flora disturbed ( e.g., via the intake of antibiotics). Bifidobacterium furthermore has the potential of outcompeting potentially harmful intestinal microorganisms.
- galactooligosaccharides are known to enhance the growth of beneficial microorganisms such as Bifidobacterium. This effect is likely achieved through the unique ability of Bifidobacterium to exploit galactooligosaccharides as a carbon source.
- dietary supplements of galactooligosaccharides are thought to have a number of long-term disease protecting effects.
- WO2012/010597 shows that the truncation variant OLGA347 transfers a galactose moiety to D-fucose, N-acetyl-galactosamine and xylose.
- U.S. Patent Publication No. US2012/0040051 describes a process for preparing easily absorbable milk products with high galactooligosaccharide (GOS) content and low lactose content, and a galactooligosaccharide-enhanced milk product prepared with the process using for example lactases from any origin, including, lactases from Aspergillus, Saccharomyces and Kluyveromyces.
- EP0458358 discloses a skim milk powder containing galactooligosaccharide (GOS) and a process for producing the same, wherein the process comprises adding ⁇ -galactosidase to concentrated milk to give rise to an enzymatic reaction and heating the reaction mixture to 75-80°C to terminate the enzymatic reaction, followed by spray drying of the reaction mixture.
- GOS galactooligosaccharide
- dairy related food products and applications thereof are highly sensitive towards numerous "non-target” (i.e., unwanted/undesirable) enzyme activities, which are also referred to in the art as “enzyme side activity” or "enzymatic side activity".
- enzyme side activity or "enzymatic side activity”.
- small amounts of cellulase, pectinase, amylase, protease, mannanase and the like enzymatic activities are undesirable in most dairy related products (i.e., unwanted/undesirable enzymatic side activities), as many dairy products are formulated/stabilized with hydrocolloids such as carboxymethyl cellulose (CMC), guar (GUAR gum), starch, carrageenan, pectin and the like.
- CMC carboxymethyl cellulose
- GUI guar
- the present disclosure addresses an ongoing need in the art for efficiently and inexpensively producing high quantities of ⁇ -galactosidases and lactases in microbial host cells, wherein such ⁇ -galactosidases and lactases produced therefrom are added to dairy products for the production of galactooligosaccharide (GOS) compositions therein. More particularly, the instant disclosure addresses the ongoing and unmet need for efficiently and inexpensively producing high quantities of ⁇ -galactosidases and lactases in Bacillus spp. host cells, wherein such enzymes produced and purified from the Bacillus spp.
- GOS galactooligosaccharide
- host cells are free of unwanted/undesirable enzymatic side activities including, but not limited to, lipase side activities, phospholipase side activities, cellulase side activities, pectinase side activities, amylase side activities, protease side activities, mannanase side activities and the like.
- WO2016/071504 discloses a host cell capable of expressing a polypeptide having ⁇ -galactosidase and/or transgalactosylating activity.
- the host cell described in WO2016/071504 is modified to be cellulase, mannanase and pectinase deficient.
- a first aspect of the invention provides a Bacillus sp. host cell expressing a polypeptide comprising ⁇ -galactosidase activity or transgalactosylating activity, wherein the host cell comprises a genetic modification which reduces or eliminates para -nitrobenzylesterase (p-NBE) activity, wherein the modification comprises a deletion or disruption of an endogenous Bacillus gene which encodes a para- nitrobenzylesterase and wherein the Bacillus sp. host cell comprises an expression vector comprising a polynucleotide encoding the polypeptide comprising ⁇ -galactosidase activity or transgalactosylating activity.
- p-NBE para -nitrobenzylesterase
- the disclosure relates to Bacillus (host) cells expressing a polypeptide comprising ⁇ -galactosidase activity or transgalactosylating activity, wherein the host cell comprises a genetic modification which reduces or eliminates para-nitrobenzylesterase ( p -NBE) activity.
- a genetic modification i.e., which reduces or eliminates p -NBE activity in the modified cell
- a genetic modification comprises a complete or partial deletion of a gene encoding a p -NBE polypeptide comprising at least 60% sequence identity to the p -NBE polypeptide of SEQ ID NO: 2.
- a partial deletion comprises deleting one or more codons encoding the p -NBE active site amino acids Ser 189 , Glu 310 and/or His 399 .
- a partial deletion comprises a nucleotide frameshift deletion in the gene encoding the p -NBE, wherein the frameshift deletion results in an encoded protein thereof lacking p -NBE activity.
- a partial deletion of a gene encoding a p -NBE polypeptide comprises deleting nucleotides of the p -NBE gene encoding amino acid residues 1-163 of SEQ ID NO: 2, deleting nucleotides of the p -NBE gene encoding amino acid residues 164-326 of SEQ ID NO: 2, deleting nucleotides of the p -NBE gene encoding amino acid residues 327-489 of SEQ ID NO: 2 or a combination thereof.
- a partial deletion of a gene encoding a p -NBE polypeptide comprises deleting the acetyl esterase (AE) domain encoded by the p -NBE gene.
- AE acetyl esterase
- the AE domain is comprised within amino acid residues 85-211 of SEQ ID NO: 2. In another embodiment, the AE domain is comprised within amino acid residues 85-211 of a polypeptide comprising at least 60% sequence identity to SEQ ID NO: 2. In yet other embodiments, a partial deletion of a gene encoding a p -NBE polypeptide comprises deleting one or more codons of the gene which encode the p -NBE substrate binding pocket.
- the genetic modification comprises a disruption of a gene encoding a p -NBE polypeptide comprising at least 60% sequence identity to the p -NBE polypeptide of SEQ ID NO: 2.
- a p -NBE gene disruption comprises the insertion of a selectable marker into the p -NBE gene, thereby disrupting the p -NBE gene coding sequence.
- a gene encoding a p -NBE polypeptide comprising at least 60% sequence identity to SEQ ID NO: 2 is disrupted by insertion of a selectable marker.
- the endogenous gene encoding the p -NBE polypeptide is disrupted ( e.g., via a disruption cassette comprising a selectable marker) at a nucleotide position encoding a p -NBE substrate binding pocket residue, a p -NBE active site catalytic triad residue, a region of the p -NBE AE domain, at the -1, 0, +1 transcription start site, in the 5' promoter region, and the like.
- the polypeptide comprising ⁇ -galactosidase activity or transgalactosylating activity is selected from the group consisting of a Bifidobacterium bifidum polypeptide comprising 90% sequence identity to SEQ ID NO: 4, SEQ ID NO: 6, SEQ ID NO: 8, SEQ ID NO: 10, SEQ ID NO: 12, SEQ ID NO: 14 or SEQ ID NO: 16, a Kluyveromyces lactis polypeptide comprising 90% sequence identity to SEQ ID NO: 17, an Aspergillus oryzae polypeptide comprising 90% sequence identity to SEQ ID NO: 18 or a Lactobacillus delbrueckii polypeptide comprising 90% sequence identity to SEQ ID NO: 26.
- polypeptide comprising ⁇ -galactosidase activity or transgalactosylating activity is encoded by a polynucleotide comprising 90% sequence identity to SEQ ID NO: 3, SEQ ID NO: 5, SEQ ID NO: 7, SEQ ID NO: 9, SEQ ID NO: 11, SEQ ID NO: 13, SEQ ID NO: 15 or SEQ ID NO: 25.
- the Bacillus host cell is selected from the group consisting of B. subtilis, B. licheniformis, B. lentus, B. brevis, B. stearothermophilus, B. alkalophilus, B. amyloliquefaciens, B. clausii, B. sonorensis, B. halodurans, B. pumilus, B. lautus, B. pabuli, B. cereus, B. agaradhaerens, B akibai, B. clarkii, B. pseudofirmus, B. lehensis, B. megaterium, B. coagulans, B. circulans, B. gibsonii, and B. thuringiensis.
- the Bacillus host cell is Bacillus subtilis.
- the host cell is further modified to be deficient in detectable lipase side activities, phospholipase side activities, cellulase side activities, pectinase side activities, amylase side activities, protease side activities and/or mannanase side activities.
- the Bacillus host cell comprises an expression vector encoding a polypeptide comprising ⁇ -galactosidase activity or transgalactosylating activity.
- the Bacillus host cell is transformed with the expression vector/construct prior to performing the genetic modification which reduces or eliminates the endogenous p -NBE activity, while in other embodiments, the Bacillus host cell is transformed with the expression vector/construct after/subsequent to performing the genetic modification which reduces or eliminates the endogenous p -NBE activity.
- a second aspect of the invention provides a method for producing a polypeptide composition having ⁇ -galactosidase activity or transgalactosylating activity, wherein the polypeptide composition does not comprise detectable para -nitrobenzylesterase ( p -NBE) activity therein, the method comprising: (a) providing a parental Bacillus host cell comprising and expressing a polynucleotide construct encoding a polypeptide having ⁇ -galactosidase activity or transgalactosylating activity, (b) modifying the Bacillus host cell of step (a) by deleting, disrupting or down-regulating a gene encoding a p -NBE polypeptide comprising at least 60% sequence identity to the p -NBE polypeptide of SEQ ID NO: 2, (c) culturing the modified host cell of step (b) under conditions suitable to express the polypeptide having ⁇ -galactosidase activity or transgalactosylating activity, and
- a third aspect of the invention provides a method for producing a polypeptide composition having ⁇ -galactosidase activity or transgalactosylating activity, wherein the polypeptide composition does not comprise detectable para -nitrobenzylesterase ( p -NBE) activity therein, the method comprising: (a) obtaining a parental Bacillus host cell and modifying the parental cell by deleting, disrupting or down-regulating a gene encoding a p -NBE polypeptide comprising at least 60% sequence identity to the p -NBE polypeptide of SEQ ID NO: 2, (b) introducing into the modified cell of step (a) an expression construct encoding a polypeptide having ⁇ -galactosidase activity or transgalactosylating activity, (c) culturing the host cell of step (b) under conditions suitable to express the polypeptide having ⁇ -galactosidase activity or transgalactosylating activity, and (d) isolating the
- a fourth aspect of the invention provides a method for producing a polypeptide composition having ⁇ -galactosidase activity or transgalactosylating activity, wherein the polypeptide composition does not comprise detectable para -nitrobenzylesterase (p-NBE) activity therein, the method comprising: (a) providing a host cell as described herein, (b) culturing the host cell of step (a) under conditions suitable to express the polypeptide having ⁇ -galactosidase activity or transgalactosylating activity, and (c) isolating the polypeptide having ⁇ -galactosidase activity or transgalactosylating activity, wherein the isolated polypeptide composition having ⁇ -galactosidase activity or transgalactosylating activity does not comprise detectable p-NBE activity.
- p-NBE para -nitrobenzylesterase
- the modification comprises a deletion disruption or down-regulation of a gene encoding a p -NBE polypeptide comprising at least 60% sequence identity to the p- NBE polypeptide of SEQ ID NO: 2.
- the modification comprises the complete or partial deletion a gene encoding a p -NBE polypeptide comprising at least 60% sequence identity to the p- NBE polypeptide of SEQ ID NO: 2.
- the partial deletion comprises deleting one or more codons encoding the p -NBE active site amino acids Ser 189 , Glu 310 and/or His 399 .
- the partial deletion comprises a nucleotide frameshift deletion in the gene encoding the p -NBE, wherein the frameshift deletion results in an encoded protein thereof lacking p -NBE activity.
- the partial deletion of a gene encoding a p -NBE polypeptide comprises deleting nucleotides of the p -NBE gene encoding amino acid residues 1-163 of SEQ ID NO: 2, deleting nucleotides of the p -NBE gene encoding amino acid residues 164-326 of SEQ ID NO: 2, deleting nucleotides of the p -NBE gene encoding amino acid residues 327-489 of SEQ ID NO: 2 or a combination thereof.
- the partial deletion of a gene encoding a p -NBE polypeptide comprises deleting the acetyl esterase (AE) domain encoded by the p -NBE gene.
- AE domain is comprised within amino acid residues 85-211 of SEQ ID NO: 2.
- the partial deletion of a gene encoding a p -NBE polypeptide comprises deleting one or more codons of the gene which encode the p -NBE substrate binding pocket.
- the modification comprises a disruption of a gene encoding a p -NBE polypeptide comprising at least 60% sequence identity to the p -NBE polypeptide of SEQ ID NO: 2.
- the p -NBE gene disruption comprises the insertion of a selectable marker into the p -NBE gene.
- the modification is a down-regulation of a gene encoding a p -NBE polypeptide comprising at least 60% sequence identity to the p -NBE polypeptide of SEQ ID NO: 2.
- down-regulation of a gene encoding a p -NBE comprises introducing and expressing in the host cell an RNA molecule complementary to a gene encoding a p -NBE.
- down-regulation of a gene encoding a p -NBE comprises (a) complete or partial deletion of the endogenous p -NBE promoter nucleic acid sequence, (b) complete or partial deletion of the endogenous p -NBE terminator nucleic acid sequence, combinations thereof, and optionally deletion of other 5' UTRs and/or 3' UTR nucleic acid sequence associated with a gene encoding a p -NBE polypeptide comprising at least 60% sequence identity to the p -NBE polypeptide of SEQ ID NO: 2.
- the polypeptide comprising ⁇ -galactosidase activity or transgalactosylating activity is selected from the group consisting of a Bifidobacterium bifidum polypeptide comprising 90% sequence identity to SEQ ID NO: 4, SEQ ID NO: 6, SEQ ID NO: 8, SEQ ID NO:10, SEQ ID NO: 12, SEQ ID NO: 14, SEQ ID NO: 16, a Kluyveromyces lactis polypeptide comprising 90% sequence identity to SEQ ID NO: 17, an Aspergillus oryzae polypeptide comprising 90% sequence identity to SEQ ID NO: 18 and a Lactobacillus delbrueckii polypeptide comprising 90% sequence identity to SEQ ID NO: 26.
- polypeptide comprising ⁇ -galactosidase activity or transgalactosylating activity is encoded by a polynucleotide comprising 90% sequence identity to SEQ ID NO: 3, SEQ ID NO: 5, SEQ ID NO: 7, SEQ ID NO: 9, SEQ ID NO: 11, SEQ ID NO: 13, SEQ ID NO: 15 or SEQ ID NO: 25.
- the Bacillus host cell is selected from the group consisting of B. subtilis, B. licheniformis, B. lentus, B. brevis, B. stearothermophilus, B. alkalophilus, B. amyloliquefaciens, B. clausii, B. sonorensis, B. halodurans, B. pumilus, B. lautus, B. pabuli, B. cereus, B. agaradhaerens, B akibai, B. clarkii, B. pseudofirmus, B. lehensis, B. megaterium, B. coagulans, B. circulans, B. gibsonii, and B. thuringiensis.
- the host cell is Bacillus subtilis.
- the host cell is further modified to be deficient in detectable lipase side activities, phospholipase side activities, cellulase side activities, pectinase side activities, amylase side activities, protease side activities and/or mannanase side activities.
- the disclosure is directed to a polypeptide comprising ⁇ -galactosidase activity or transgalactosylating activity produced by the methods of the disclosure.
- the present disclosure is generally directed to modified Bacillus host cells expressing/producing ⁇ -galactosidase enzymes and/or lactase enzymes and the use of such enzymes for the production of galactooligosaccharide (GOS) compositions in one or more dairy related end products.
- GOS galactooligosaccharide
- small amounts of unwanted enzyme activity mainly originate from the production host cell and are referred to as enzyme side activity.
- the present disclosure is directed to reducing/eliminating unwanted enzyme side activities in host cells used for the production of ⁇ -galactosidase and/or lactase enzymes for use in dairy products formulations/applications.
- the disclosure is directed to expressing/producing such ⁇ -galactosidase and/or lactase enzymes in modified Bacillus host cells, wherein such enzymes produced and purified from the modified Bacillus host cells are free of unwanted/undesirable enzymatic side activities including, but not limited to, unwanted/undesirable lipase side activities, phospholipase side activities, cellulase side activities, pectinase side activities, amylase side activities, protease side activities, mannanase side activities and the like.
- the disclosure relates to genetically modifying a Bacillus host cell for the production of ⁇ -galactosidase and/or lactase enzymes in the absence of unwanted enzymatic side activities.
- a Bacillus host cell of the disclosure is genetically modified to produce ⁇ -galactosidase and/or lactase enzymes in the absence of unwanted/undesirable para -nitrobenzylesterase side activity.
- a Bacillus host cell of the disclosure is genetically modified by deleting, disrupting or down-regulating an endogenous Bacillus gene which encodes a para -nitrobenzylesterase enzyme.
- such genetically modified Bacillus host cells are particularly useful in the production of ⁇ -galactosidase and/or lactase enzymes, wherein such ⁇ -galactosidase and/or lactase enzymes are particularly free of unwanted para -nitrobenzylesterase enzymatic side-activity which causes highly undesirable off-flavors and smells when used in dairy related end-products.
- a genetically modified Bacillus host cell of the disclosure comprising a deleted, disrupted or down-regulated endogenous gene encoding a para -nitrobenzylesterase enzyme, further comprises a deleted, disrupted or down-regulated gene encoding at least one additional unwanted/undesirable enzymatic side activity selected from a lipase side activity, a phospholipase side activity, a cellulase side activity, a pectinase side activity, an amylase side activity, a protease side activity, a mannanase side activity and the like.
- a genetically modified Bacillus host cell of the disclosure i.e., comprising a genetic modification which deletes, disrupts or down-regulates an endogenous gene encoding a para- nitrobenzylesterase enzyme
- a polynucleotide e.g ., an expression construct
- the ⁇ -galactosidase and/or lactase enzymes of the disclosure which are expressed/produced in the genetically modified Bacillus host cells of the disclosure are particularly useful in dairy product applications.
- the ⁇ -galactosidase and/or lactase enzymes expressed/produced in such genetically modified Bacillus host cells which ⁇ -galactosidase and/or lactase enzymes are isolated and purified therefrom, are free of detectable para -nitrobenzylesterase side activity. More particularly, as described in the Examples herein, Applicants of the instant disclosure identified a para -nitrobenzylesterase as the enzymatic side activity responsible for the foul off-flavor smells/tastes of dairy products which were formulated with such ⁇ -galactosidase and/or lactase enzymes.
- the genetically modified Bacillus host cells of the disclosure find particular utility for the production of such ⁇ -galactosidase and/or lactase enzymes without the contaminating ( i.e., unwanted/undesirable) para -nitrobenzylesterase side activity thereof.
- transgalactosylase means an enzyme that, among other things, is able to transfer galactose to the hydroxyl groups of D-galactose or D-glucose, whereby galactooligosaccharides are produced.
- a transgalactosylase is identified by reaction of the enzyme on lactose in which the amount of galactose generated is less than the amount of glucose generated at any given time.
- transgalactosylating activity means the transfer of a galactose moiety to a molecule other than water (H 2 O).
- the transgalactosylating activity can be measured as [glucose] - [galactose] generated at any given time during the reaction, or by direct quantification of the galactooligosaccharides (GOSs) generated at any given time during the reaction.
- GOSs galactooligosaccharides
- ⁇ -galactosidase activity refers to the ability of an enzyme to hydrolyze ⁇ -galactoside molecules (e.g ., hydrolyzing lactose disaccharides into monosaccharides glucose and galactose).
- ratio the "transgalactosylating activity/ ⁇ -galactosidase activity” (ratio) the ⁇ -galactosidase activity is measured as [galactose] generated at any given time during the reaction.
- activity ratio measurements may be performed by methods known in the art (e.g., an HPLC method).
- ⁇ -galactosidase having transgalactosylating activity means a ⁇ -galactosidase having a ratio of transgalactosylation activity above 100%, such as above 105%, 125%, 150%, 175%, 200% and the like.
- Examples of ⁇ -galactosidases having transgalactosylating activity can be derived from, but are not limited to, Aspergillus oryzae, Bacillus circulans, Ruminococcus, Bifidobacterium, Geobacillus stearothermophilus, Lactobacillus delbrueckii, Bacillus stearothermophilus and Lactobacillus plantarum (Oliveira et al., 2011).
- [Glucose]” or “glucose concentration” means the glucose concentration in % by weight and the terms “[Galactose]” or “galactose concentration” means the galactose concentration in % by weight.
- lactose has been transgalactosylated means that a galactose molecule has been covalently linked to the lactose molecule, such as for example covalently linked to any of the free hydroxyl groups in the lactose molecule, or as generated by internal transgalatosylation ( e.g ., forming allolactose).
- which polypeptide is spray-dried means that the polypeptide has been obtained by spray-drying a polypeptide which is in solution or suspension at an appropriate temperature and for an appropriate period removing the water.
- milk in the context of the present disclosure, is to be understood as the lacteal secretion obtained from any mammal, such as cows, sheep, goats, buffaloes, camels and the like.
- milk-based substrate means any raw and/or processed milk material, or a material derived from milk constituents.
- the milk-based substrate may be homogenized and/or pasteurized according to methods known in the art.
- Homogenizing as used herein means intensive mixing to obtain a soluble suspension or emulsion. Homogenization may be performed so as to break up the milk fat into smaller sizes, such that the milk fat no longer separates from the milk. This may be accomplished, for example, by forcing the milk at high pressure through small orifices.
- pasteurizing means reducing or eliminating the presence of live organisms, such as microorganisms, in the milk-based substrate. Pasteurization is attained by maintaining a specified temperature and pressure for a specified period of time. The specified temperature is usually attained by heating. The temperature and duration may be selected in order to kill or inactivate certain bacteria, such as harmful bacteria, and/or to inactivate enzymes in the milk. A rapid cooling step may follow.
- a "dairy product" in the context of the present disclosure may be any food product wherein one of the major constituents is a milk-based substrate.
- the major constituent is milk-based.
- "one of the major constituents” means a constituent having a dry matter which constitutes more than 20%, preferably more than 30%, or more than 40%, of the total dry matter of the dairy product, whereas "the major constituent” means a constituent having a dry matter which constitutes more than 50%, preferably more than 60%, or more than 70%, of the total dry matter of the dairy product.
- a "fermented dairy product” in present context is to be understood as any dairy product wherein any type of fermentation forms part of the production process.
- fermented dairy products include, but are not limited to, yoghurt, buttermilk, crème fraiche, quark and fromage frais.
- Another example of a fermented dairy product is cheese.
- a fermented yogurt dairy product is a set-type yoghurt, a stirred yoghurt or a drinking yogurt.
- a fermented dairy product is Acidophilus milk, ja milk, Ayran milk, Kefir milk or Sauermilch milk.
- Such fermented dairy products may be produced by any method known in the art.
- an "isolated polynucleotide” refers to a polynucleotide that is isolated from a source.
- the polynucleotide is at least 1% pure, preferably at least 5% pure, more preferably at least 10% pure, more preferably at least 20% pure, more preferably at least 40% pure, more preferably at least 60% pure, even more preferably at least 80% pure, and most preferably at least 90% pure, as determined by agarose electrophoresis.
- a substantially pure polynucleotide refers to a polynucleotide preparation free of other extraneous or unwanted nucleotides and in a form suitable for use within genetically engineered protein production systems.
- a substantially pure polynucleotide contains at most 10%, preferably at most 8%, more preferably at most 6%, more preferably at most 5%, more preferably at most 4%, more preferably at most 3%, even more preferably at most 2%, most preferably at most 1%, and even most preferably at most 0.5% by weight of other polynucleotide material with which it is natively or recombinantly associated.
- a substantially pure polynucleotide may, however, include naturally occurring 5' and 3' untranslated regions, such as promoters and terminators. It is preferred that the substantially pure polynucleotide is at least 90% pure, preferably at least 92% pure, more preferably at least 94% pure, more preferably at least 95% pure, more preferably at least 96% pure, more preferably at least 97% pure, even more preferably at least 98% pure, most preferably at least 99%, and even most preferably at least 99.5% pure by weight.
- the polynucleotides are preferably in a substantially pure form (i.e., that the polynucleotide preparation is essentially free of other polynucleotide material with which it is natively or recombinantly associated).
- the polynucleotides may be of genomic, cDNA, RNA, semisynthetic, synthetic origin, or any combinations thereof.
- an "isolated polypeptide” refers to a polypeptide that is isolated from a source.
- the polypeptide is at least 1% pure, preferably at least 5% pure, more preferably at least 10% pure, more preferably at least 20% pure, more preferably at least 40% pure, more preferably at least 60% pure, even more preferably at least 80% pure, and most preferably at least 90% pure, as determined by SDS-PAGE.
- a "substantially pure polypeptide” denotes herein a polypeptide preparation that contains at most 10%, preferably at most 8%, more preferably at most 6%, more preferably at most 5%, more preferably at most 4%, more preferably at most 3%, even more preferably at most 2%, most preferably at most 1%, and even most preferably at most 0.5% by weight of other polypeptide material with which it is natively or recombinantly associated.
- the substantially pure polypeptide is at least 92% pure, preferably at least 94% pure, more preferably at least 95% pure, more preferably at least 96% pure, more preferably at least 96% pure, more preferably at least 97% pure, more preferably at least 98% pure, even more preferably at least 99%, most preferably at least 99.5% pure, and even most preferably 100% pure by weight of the total polypeptide material present in the preparation.
- the polypeptides are preferably in a substantially pure form (i.e., that the polypeptide preparation is essentially free of other polypeptide material with which it is natively or recombinantly associated). This can be accomplished, for example, by preparing the polypeptide by well-known recombinant methods or by classical purification methods.
- a "substantially pure ⁇ -galactosidase polypeptide” and a “substantially pure lactase polypeptide” refer to a polypeptide preparation that contains at most 10%, preferably at most 8%, more preferably at most 6%, more preferably at most 5%, more preferably at most 4%, more preferably at most 3%, even more preferably at most 2%, most preferably at most 1%, and even most preferably at most 0.5% by weight of other polypeptide material with which it is natively or recombinantly associated.
- the substantially pure polypeptide is at least 92% pure, preferably at least 94% pure, more preferably at least 95% pure, more preferably at least 96% pure, more preferably at least 96% pure, more preferably at least 97% pure, more preferably at least 98% pure, even more preferably at least 99%, most preferably at least 99.5% pure, and even most preferably 100% pure by weight of the total polypeptide material present in the preparation.
- a "substantially pure ⁇ -galactosidase polypeptide” and a “substantially pure lactase polypeptide” refer to such polypeptides which are essentially free of detectable "p-nitrobenzylesterase activity”.
- a substantially pure ⁇ -galactosidase polypeptide composition and/or a substantially pure lactase polypeptide composition, which are completely free of detectable "p-nitrobenzylesterase activity" can be obtained by expressing/producing such ⁇ -galactosidase polypeptides and/or lactase polypeptides in the genetically modified Bacillus host cell of the disclosure (i.e., a Bacillus host cell comprising a deletion, disruption or down-regulation of a gene (e.g. , SEQ ID NO: 1) encoding p-nitrobenzylesterase of SEQ ID NO: 2.
- a substantially pure " ⁇ -galactosidase polypeptide” or a “substantially pure lactase polypeptide” is essentially free of detectable p-nitrobenzylesterase activity and is essentially free of at least one additional unwanted side activity selected from the group consisting of cellulase activity, mannanase activity, pectinase activity, amylase activity, protease activity and the like.
- the term “substantially free from cellulase” means a preparation which contains at most 10%, preferably at most 8%, more preferably at most 6%, more preferably at most 5%, more preferably at most 4%, at most 3%, even more preferably at most 2%, most preferably at most 1 %, and even most preferably at most 0.5% by weight of cellulase.
- the term “substantially free from” can therefore be seen as being synonymous with the terms “isolated polypeptide” and "polypeptide in isolated form.”
- the term "substantially free from mannanase” means herein a preparation which contains at most 10%, preferably at most 8%, more preferably at most 6%, more preferably at most 5%, more preferably at most 4%, at most 3%, even more preferably at most 2%, most preferably at most 1 %, and even most preferably at most 0.5% by weight of mannanase.
- the term “substantially free from” can therefore be seen as being synonymous with the terms “isolated polypeptide” and "polypeptide in isolated form.”
- the term "substantially free from pectinase” means herein a preparation which contains at most 10%, preferably at most 8%, more preferably at most 6%, more preferably at most 5%, more preferably at most 4%, at most 3%, even more preferably at most 2%, most preferably at most 1 %, and even most preferably at most 0.5% by weight of pectinase.
- the term “substantially free from” can therefore be seen as being synonymous with the terms “isolated polypeptide” and "polypeptide in isolated form.”
- the term "substantially free from amylase” means herein a preparation which contains at most 10%, preferably at most 8%, more preferably at most 6%, more preferably at most 5%, more preferably at most 4%, at most 3%, even more preferably at most 2%, most preferably at most 1 %, and even most preferably at most 0.5% by weight of amylase.
- the term “substantially free from” can therefore be seen as being synonymous with the terms “isolated polypeptide” and "polypeptide in isolated form.”
- the term "stabilizer” means any stabilizer for stabilizing the polypeptide, e.g ., a polyol such as glycerol or propylene glycol, a sugar or a sugar alcohol, lactic acid, boric acid, or a boric acid derivative (e.g ., an aromatic borate ester).
- the stabilizer is not a polyol, or the polyol is present at a level of 0.1 weight % or less.
- an "endogenous gene” refers to a gene in its natural location in the genome of an organism.
- a “heterologous” gene, a “non-endogenous” gene, or a “foreign” gene refer to a gene (or ORF) not normally found in the host organism, but that is introduced into the host organism by gene transfer.
- the term “heterologous” gene(s) comprise native genes (or ORFs) inserted into a non-native organism and/or chimeric genes inserted into a native or non-native organism.
- the terms "foreign polynucleotide” or “heterologous polynucleotide” are defined as (A) a polynucleotide that is not native to the host cell, (B) a polynucleotide that is native to the host cell, but which polynucleotide has been modified through the use of genetic elements which are not natively associated with the polynucleotide (e.g. , heterologous promoters, 5' UTRs, 3' UTRs and the like) as isolated from the host cell, or (C) the use of native elements that have been manipulated to function in a manner that does not normally occur in the host cell.
- a “heterologous" nucleic acid construct or a “heterologous” nucleic acid sequence has a portion of the sequence which is not native to the cell in which it is expressed.
- a "transformed cell” includes bacterial cells (e.g., Bacillus cells) which have been transformed by use of recombinant DNA techniques. Transformation generally occurs via the introduction of one or more nucleotide sequences (e.g. , polynucleotides) into a cell.
- the introduced nucleotide sequence(s) may also be a heterologous nucleotide sequence (i.e., a nucleic sequence not endogenous to the cell).
- nucleic acid construct refers to a nucleic acid molecule (e.g ., a polynucleotide molecule), either single-stranded or double-stranded, which is isolated from a naturally occurring gene or is modified to contain segments of nucleic acids in a manner that would not otherwise exist in nature or is synthetic.
- nucleic acid construct is synonymous with the term “expression cassette” when the nucleic acid construct contains the control sequences required for expression of a coding sequence.
- control sequences is defined to include all components, which are necessary or advantageous for the expression of a polynucleotide encoding a polypeptide of the present invention.
- Each control sequence may be native or foreign to the polynucleotide encoding the polypeptide or native or foreign to each other.
- control sequences include, but are not limited to, a leader, polyadenylation sequence, propeptide sequence, promoter, signal peptide sequence, and transcription terminator.
- the control sequences include a promoter, and transcriptional and translational stop signals.
- the control sequences may be provided with linkers for the purpose of introducing specific restriction sites facilitating ligation of the control sequences with the coding region of the nucleotide sequence encoding a polypeptide.
- heterologous control sequence refers to a gene expression control sequence (e.g., a promoter or enhancer) which does not function in nature to regulate (control) the expression of the gene of interest.
- heterologous nucleic acid sequences are not endogenous (native) to the cell, or a part of the genome in which they are present, and have been added to the cell, by infection, transfection, transformation, microinjection, electroporation, and the like.
- a “heterologous” nucleic acid construct may contain a control sequence/DNA coding (ORF) sequence combination that is the same as, or different, from a control sequence/DNA coding sequence combination found in the native host cell.
- ORF control sequence/DNA coding
- promoter is defined as a DNA sequence that binds RNA polymerase and directs the polymerase to the correct downstream transcriptional start site of a polynucleotide encoding a polypeptide. RNA polymerase effectively catalyzes the assembly of messenger RNA complementary to the appropriate DNA strand of the coding region.
- the term “promoter” will also be understood to include the 5' non-coding region (between promoter and translation start) for translation after transcription into mRNA, cis-acting transcription control elements such as enhancers, and/or other nucleotide sequences capable of interacting with transcription factors.
- the promoter can be a wild-type, variant, hybrid, or a consensus promoter.
- promoter region is defined as a nucleotide sequence comprising one or more (several) promoter sequences (e.g ., a dual promoter, a triple promoter and the like).
- operably linked denotes a configuration in which a control sequence (e.g., a promoter sequence) is placed at an appropriate position relative to the coding sequence of the polynucleotide sequence such that the control sequence directs the expression of the coding sequence of a polypeptide.
- Coding sequence means a nucleotide sequence, which directly specifies the amino acid sequence of its protein product. The boundaries of the coding sequence are generally determined by an open reading frame, which usually begins with the ATG start codon or alternative start codons such as GTG and TTG and ends with a stop codon such as TAA, TAG and TGA.
- the coding sequence may be a DNA, cDNA, synthetic, or recombinant nucleotide sequence.
- variants may refer to either polypeptides or nucleic acids.
- variant may be used interchangeably with the term “mutant”.
- variants include insertions, substitutions, transversions, truncations, deletions and/or inversions at one or more locations in the amino acid or nucleotide sequence.
- POI polypeptide of interest
- an "expression vector” and “expression construct” are used interchangeably and refer to a linear or circular DNA molecule that comprises a polynucleotide encoding a polypeptide of interest, and is operably linked to additional nucleotides that provide for its expression.
- one of the major constituents means a constituent having a dry matter which constitutes more than 20%, preferably more than 30% or more than 40% of the total dry matter of the dairy product, whereas "the major constituent” means a constituent having a dry matter which constitutes more than 50%, preferably more than 60% or more than 70% of the total dry matter of the dairy product.
- a host cell refers to a cell or cell line into which a recombinant expression vector for production of a polypeptide may be introduced for expression of the polypeptide.
- a host cell of the disclosure comprises an expression construct encoding a ⁇ -galactosidase and/or lactase enzyme of the disclosure.
- Host cells include progeny of a single host cell, and the progeny may not necessarily be completely identical (in morphology or in total genomic DNA complement) to the original parent cell due to natural, accidental, or deliberate mutation.
- a host cell includes cells transfected or transformed in vivo with an expression vector.
- a "modified host cell”, an “altered host cell” and a “genetically modified host cell” are used interchangeably and refer to recombinant host cells that comprise at least a modification which deletes disrupts or down-regulates a gene encoding a p -nitrobenzylesterase polypeptide comprising at least 60% sequence identity to the p -nitrobenzylesterase polypeptide of SEQ ID NO: 2.
- a "genetically modified" host cell of the instant disclosure may be further defined as a “genetically modified (host) cell” which is derived from a parental host cell, wherein the modified (daughter) cell comprises at least a modification which deletes, disrupts or down-regulates a gene encoding a p -nitrobenzylesterase polypeptide comprising at least 60% sequence identity to the p -nitrobenzylesterase polypeptide of SEQ ID NO: 2.
- an "unmodified cell”, an “unaltered cell”, an “unmodified host cell”, and an “unaltered host cell” are used interchangeably and refer to "unmodified” (parental) host cells that do not comprise a modification which deletes, disrupts or down-regulates a gene encoding a p -nitrobenzylesterase polypeptide comprising at least 60% sequence identity to the p -nitrobenzylesterase polypeptide of SEQ ID NO: 2.
- the "unmodified" (parental) host cell may be referred to as a "control cell”, particularly when being compared with, or relative to, a "modified” (daughter) host cell of the disclosure.
- modification and “genetic modification” are used interchangeably and include: (a) the introduction, substitution, or removal of one or more nucleotides in a gene (or an ORF thereof), or the introduction, substitution, or removal of one or more nucleotides in a regulatory/control element required for the transcription or translation of the gene or ORF thereof, (b) a gene disruption, (c) a gene conversion, (d) a gene deletion, (e) the down-regulation of a gene, (f) specific mutagenesis and/or (g) random mutagenesis of any one or more the genes disclosed herein.
- disruption of a gene As used herein, “disruption of a gene”, “gene disruption”, “inactivation of a gene” and “gene inactivation” are used interchangeably and refer broadly to any genetic modification that substantially prevents a host cell from producing a functional gene product (e.g., a protein).
- exemplary methods of gene disruptions include complete or partial deletion of any portion of a gene, including a polypeptide-coding sequence, a promoter, an enhancer, or another regulatory element, or mutagenesis of the same, where mutagenesis encompasses substitutions, insertions, deletions, inversions, and any combinations and variations thereof which disrupt/inactivate the target gene(s) and substantially reduce or prevent the production of the functional gene product ( i.e., a protein).
- the terms "down-regulation" of gene expression include any method that results in lower (down-regulated) expression of a gene.
- the down-regulation of a gene can be achieved by RNA-induced gene silencing, genetic modifications of control elements such as the promoter, ribosomal binding site (RBS)/Shine-Dalgarno sequences, untranslated regions (UTRs), codon changes, and the like.
- a Bacillus (host) cell of the disclosure comprising a gene encoding an unwanted para -nitrobenzylesterase (p-NBE) activity is genetically modified to down-regulate the expression of the p-NBE gene.
- p-NBE para -nitrobenzylesterase
- recombinant when used in reference to a cell, nucleic acid, protein or vector, indicates that the cell, nucleic acid, protein or vector, has been modified by the introduction of a heterologous nucleic acid or protein or the alteration of a native nucleic acid or protein, or that the cell is derived from a cell so modified.
- recombinant cells express genes that are not found within the native (non-recombinant) form of the cell or express native genes that are otherwise abnormally expressed, under expressed or not expressed at all.
- the term “culturing” refers to growing a population of microbial cells under suitable conditions for growth, in a liquid or solid culture medium.
- culture medium refers to the medium used in this process.
- the term "introduced” in the context of inserting a nucleic acid sequence into a cell includes “transfection”, “transformation”, or “transduction”, and refers to the incorporation of a nucleic acid sequence into a eukaryotic or prokaryotic cell, wherein the nucleic acid sequence may be incorporated into the genome of the cell (e.g ., chromosome, plasmid, plastid, or mitochondrial DNA), converted into an autonomous replicon, or transiently expressed.
- transformed refers to a cell that has an introduced (exogenous) nucleic acid sequence integrated into its genome or as an episomal plasmid that is maintained through multiple generations.
- the term “gene”, refers to a polynucleotide that codes for a particular sequence of amino acids, which comprise all, or part of a protein coding sequence, and may include regulatory (non-transcribed) DNA sequences, such as promoter sequences, which determine for example the conditions under which the gene is expressed.
- the transcribed region of the gene may include untranslated regions (UTRs), including introns, 5'-untranslated regions (UTRs), and 3'-UTRs, as well as the coding sequence.
- coding sequence refers to a nucleotide sequence, which directly specifies the amino acid sequence of its (encoded) protein product.
- the boundaries of the coding sequence are generally determined by an open reading frame (hereinafter, "ORF"), which usually begins with an ATG start codon.
- ORF open reading frame
- the coding sequence typically includes DNA, cDNA, and recombinant nucleotide sequences.
- ORF open reading frame
- a "targeting vector” is a vector that includes polynucleotide sequences that are homologous to a region in the chromosome of a host cell into which the targeting vector is transformed and that can drive homologous recombination at that region.
- targeting vectors find use in introducing mutations into the chromosome of a host cell through homologous recombination.
- the targeting vector comprises other non-homologous sequences, e.g., added to the ends (i.e., stuffer sequences or flanking sequences). The ends can be closed such that the targeting vector forms a closed circle, such as, for example, insertion into a vector. Selection and/or construction of appropriate vectors is well within the knowledge of those having skill in the art.
- homologous genes refers to a pair of genes from different, but usually related species, which correspond to each other and which are identical or very similar to each other.
- the term encompasses genes that are separated by speciation (i.e., the development of new species) (e.g., orthologous genes), as well as genes that have been separated by genetic duplication (e.g. , paralogous genes).
- orthologous genes refer to genes in different species that have evolved from a common ancestral gene (i.e., a homologous gene) by speciation. Typically, orthologs retain the same function during the course of evolution. Identification of orthologs finds use in the reliable prediction of gene function in newly sequenced genomes.
- paralogous genes refer to genes that are related by duplication within a genome. While orthologs retain the same function through the course of evolution, paralogs evolve new functions, even though some functions are often related to the original one. Examples of paralogous genes include, but are not limited to genes encoding trypsin, chymotrypsin, elastase, and thrombin, which are all serine proteinases and occur together within the same species.
- homology refers to sequence similarity or identity, with identity being preferred. This homology is determined using standard techniques known in the art (see e.g., Smith and Waterman, 1981; Needleman and Wunsch, 1970; Pearson and Lipman, 1988; programs such as GAP, BESTFIT, FASTA, and TFASTA in the Wisconsin Genetics Software Package (Genetics Computer Group, Madison, WI) and Devereux et. al., 1984).
- an "analogous sequence” is one wherein the function of the gene (e.g. , a para -nitrobenzylesterase) is essentially the same as the para- nitrobenzylesterase gene derived from a Bacillus cell of the disclosure. Additionally, analogous genes include at least 60%, 65%, 70%, 75%, 80%, 85%, 90%, 95%, 97%, 98%, 99% or 100% sequence identity with the para-nitrobenzylesterase sequence of SEQ ID NO: 1. Analogous sequences are determined by known methods of sequence alignment. A commonly used alignment method is BLAST, although there are other methods that also find use in aligning sequences.
- hybridization refers to the process by which a strand of nucleic acid joins with a complementary strand through base pairing, as known in the art.
- a nucleic acid sequence is considered to be “selectively hybridizable” to a reference nucleic acid sequence if the two sequences specifically hybridize to one another under moderate to high stringency hybridization and wash conditions.
- Hybridization conditions are based on the melting temperature (T m ) of the nucleic acid binding complex or probe.
- maximum stringency typically occurs at about T m - 5°C (5°below the T m of the probe); “high stringency” at about 5-10°C below the T m ; “intermediate stringency” at about 10-20°C below the T m of the probe; and “low stringency” at about 20-25°C below the T m .
- maximum stringency conditions may be used to identify sequences having strict identity or near-strict identity with the hybridization probe; while an intermediate or low stringency hybridization can be used to identify or detect polynucleotide sequence homologs. Moderate and high stringency hybridization conditions are well known in the art.
- An example of high stringency conditions includes hybridization at about 42°C in 50% formamide, 5X SSC, 5X Denhardt's solution, 0.5% SDS and 100 pg/ml denatured carrier DNA, followed by washing two times in 2X SSC and 0.5% SDS at room temperature (RT) and two additional times in 0. 1X SSC and 0.5% SDS at 42°C.
- An example of moderate stringent conditions including overnight incubation at 37°C in a solution comprising 20% formamide, 5 x SSC (150mM NaCI, 15 mM trisodium citrate), 50 mM sodium phosphate (pH 7.6), 5 x Denhardt's solution, 10% dextran sulfate and 20 mg/ml denaturated sheared salmon sperm DNA, followed by washing the filters in 1x SSC at about 37-50°C.
- Those of skill in the art know how to adjust the temperature, ionic strength, etc. as necessary to accommodate factors such as probe length and the like.
- a "flanking sequence” refers to any sequence that is either upstream or downstream of the sequence being discussed (e.g. , for genes A-B-C, gene B is flanked by the A and C gene sequences).
- the incoming sequence is flanked by a homology box on each side.
- the incoming sequence and the homology boxes comprise a unit that is flanked by stuffer sequence on each side.
- a flanking sequence is present on only a single side (either 3' or 5'), but in preferred embodiments, it is on each side of the sequence being flanked.
- the sequence of each homology box is homologous to a sequence in the Bacillus chromosome.
- sequences direct where in the Bacillus chromosome the new construct gets integrated and what part of the Bacillus chromosome will be replaced by the incoming sequence.
- the 5' and 3' ends of a selective marker are flanked by a polynucleotide sequence comprising a section of the inactivating chromosomal segment.
- a flanking sequence is present on only a single side (either 3' or 5'), while in other embodiments, it is present on each side of the sequence being flanked.
- stuffer sequence refers to any extra DNA that flanks homology boxes (typically vector sequences). However, the term encompasses any non- homologous DNA sequence. Not to be limited by any theory, a stuffer sequence provides a non-critical target for a cell to initiate DNA uptake.
- Plasmid refers to extrachromosomal elements, often carrying genes which are typically not part of the central metabolism of the cell, and usually in the form of circular double-stranded DNA molecules.
- Such elements may be autonomously replicating sequences, genome integrating sequences, phage or nucleotide sequences, linear or circular, of a single-stranded or double-stranded DNA or RNA, derived from any source, in which a number of nucleotide sequences have been joined or recombined into a unique construction which is capable of introducing a promoter fragment and DNA sequence for a selected gene product along with appropriate 3' untranslated sequence into a cell.
- selectable marker refers to a nucleic acid (e.g., a gene) capable of expression in host cell which allows for ease of selection of those hosts containing the vector.
- selectable markers include, but are not limited to, antimicrobials.
- selectable marker refers to genes that provide an indication that a host cell has taken up an incoming DNA of interest or some other reaction has occurred.
- selectable markers are genes that confer antimicrobial resistance or a metabolic advantage on the host cell to allow cells containing the exogenous DNA to be distinguished from cells that have not received any exogenous sequence during the transformation.
- selectable marker-encoding nucleotide sequence refers to a nucleotide sequence which is capable of expression in the host cells and where expression of the selectable marker confers to cells containing the expressed gene the ability to grow in the presence of a corresponding selective agent or lack of an essential nutrient.
- the genus Bacillus includes all species within the genus " Bacillus "' as known to those of skill in the art, including but not limited to B. subtilis, B. licheniformis, B. lentus, B. brevis, B. stearothermophilus, B. alkalophilus, B. amyloliquefaciens, B. clausii, B. halodurans, B. megaterium, B. coagulans, B. circulans, B. lautus, and B. thuringiensis. It is recognized that the genus Bacillus continues to undergo taxonomical reorganization. Thus, it is intended that the genus include species that have been reclassified, including but not limited to such organisms as B. stearothermophilus, which is now named "Geobacillus stearothermophilus".
- enzyme products e.g. , a ⁇ -galactosidase product
- small amounts of unwanted enzyme activity mainly originate from the production host cell and are referred to as enzyme side activity.
- the present disclosure is directed to reducing unwanted enzyme side activities in host cells used for the production of ⁇ -galactosidase and/or lactase enzymes for use in dairy products formulations/applications.
- the enzyme activity in dairy applications should preferably be measured at the appropriate pH and temperature for the particular application.
- the pH varies from 6.4 to 6.8, yoghurt pH is approximately 4, infant formula pH ranges from 5.9 -7.3, mozzarella has a pH 5.2-5.5 and mayonnaise pH 4.
- the level of undesirable activity can be determined by application tests in each intended application.
- GOS galactooligosaccharide
- certain embodiments are directed to expressing/producing such ⁇ -galactosidase and/or lactase enzymes in modified Bacillus host cells, wherein such enzymes produced and purified from the modified Bacillus host cells are free of unwanted/undesirable enzymatic side activities including, but not limited to, unwanted/undesirable lipase side activities, phospholipase side activities, cellulase side activities, pectinase side activities, amylase side activities, protease side activities, mannanase side activities and the like.
- such ⁇ -galactosidase and/or lactase enzymes are produced in genetically modified Bacillus host cells and purified therefrom, wherein such purified enzymes are free of unwanted/undesirable p -nitrobenzylesterase activity.
- a substantially pure ⁇ -galactosidase polypeptide composition and/or a substantially pure lactase polypeptide composition, which are completely free of detectable " p -nitrobenzylesterase activity" are obtained by expressing/producing such ⁇ -galactosidase polypeptides and/or lactase polypeptides in a genetically modified Bacillus host cell of the disclosure, wherein the modified Bacillus host cells comprises a deletion, disruption or down-regulation of a gene (e.g., SEQ ID NO: 1) encoding a p -nitrobenzylesterase of SEQ ID NO: 2.
- a modified Bacillus (daughter) cell of the disclosure i.e., comprising a deleted, disrupted or down-regulated gene (e.g., SEQ ID NO: 1) encoding a p -nitrobenzylesterase (e.g., SEQ ID NO: 2) completely eliminated the unwanted/undesirable p- nitrobenzylesterase side activity from the ⁇ -galactosidase and/or lactase products produced therefrom.
- a deleted, disrupted or down-regulated gene e.g., SEQ ID NO: 1
- a p -nitrobenzylesterase e.g., SEQ ID NO: 2
- the elimination (e.g ., deletion) of the gene encoding the unwanted/undesirable p -nitrobenzylesterase side activity i.e., in the modified Bacillus host cells of the disclosure
- certain embodiments of the disclosure are directed to the expression/production of ⁇ -galactosidases and/or lactases in modified Bacillus host cells comprising a deleted, disrupted or down-regulated gene encoding a p -nitrobenzylesterase comprising 60% sequence identity to the p- nitrobenzylesterase of SEQ ID NO: 2.
- a modified Bacillus host cell of the disclosure i.e.
- modified Bacillus host cells described herein are suitable for the expression/production of any ⁇ -galactosidase or lactase enzyme, wherein the purified ⁇ -galactosidase or lactase enzyme compositions and products thereof are free of detectable p -nitrobenzylesterase side activity.
- PCT International Publication Nos. WO2016/071504 , WO2016/071500 , WO2015/086746 and WO2011/120993 disclose various ⁇ -galactosidase or lactase enzymes having transgalactosylating activity (and variants thereof having transgalactosylating activity).
- the enzymes disclosed in PCT International Publication Nos. WO2016/071504 , WO2016/071500 , WO2015/086746 and WO2011/120993 are particularly suitable for expression/production in the modified Bacillus host cells of the present disclosure.
- a ⁇ -galactosidase or lactase enzyme having transgalactosylating activity
- a modified Bacillus host cell of the disclosure is not intended to be limited to a particular ⁇ -galactosidase or lactase amino acid sequence (or a particular gene/polynucleotide sequence encoding the same), so long as the ⁇ -galactosidase or lactase enzyme (having transgalactosylating activity) can be expressed/produced in the modified Bacillus host cell and is free of detectable p -nitrobenzylesterase activity.
- a ⁇ -galactosidase or lactase polypeptide to be expressed in a modified Bacillus host cell of the disclosure comprises an amino acid sequence selected from SEQ ID NO: 4, SEQ ID NO: 6, SEQ ID NO: 8, SEQ ID NO: 10, SEQ ID NO: 12, SEQ ID NO: 14, SEQ ID NO: 16, SEQ ID NO: 17, SEQ ID NO: 18 and SEQ ID NO: 26.
- a ⁇ -galactosidase or lactase polypeptide to be expressed in a modified Bacillus host cell of the disclosure comprises an amino acid sequence comprising about 80% sequence identity to any one of SEQ ID NO: 4, SEQ ID NO: 6, SEQ ID NO: 8, SEQ ID NO: 10, SEQ ID NO: 12, SEQ ID NO: 14, SEQ ID NO: 16, SEQ ID NO: 17, SEQ ID NO: 18 and SEQ ID NO: 2.
- a ⁇ -galactosidase or lactase polypeptide to be expressed in a modified Bacillus host cell of the disclosure comprises a partial or truncated amino acid sequence of SEQ ID NO: 4.
- the disclosure is directed to polypeptides having a ratio of transgalactosylating activity/ ⁇ -galactosidase activity of at least 0.5, at least 1, at least 2, at least 2.5, at least 3, at least 4, at least 5, at least 6, at least 7, at least 8, at least 9, at least 10, at least 11, or at least 12 at or above a concentration of 3% w/w initial lactose concentration.
- a polypeptide having transgalactosylating activity is selected from the group consisting of (a) a polypeptide comprising an amino acid sequence having at least 90% sequence identity with SEQ ID NO: 6, wherein the polypeptide consists of at most 980 amino acid residues, (b) a polypeptide comprising an amino acid sequence having at least 97% sequence identity with SEQ ID NO: 8, wherein the polypeptide consists of at most 975 amino acid residues, (c) a polypeptide comprising an amino acid sequence having at least 96.5% sequence identity with SEQ ID NO: 10, wherein the polypeptide consists of at most 1,300 amino acid residues, (d) a polypeptide encoded by a polynucleotide that hybridizes under at least low stringency conditions with a nucleic acid sequence comprised in SEQ ID NO: 3, 5, 7, 9 , 11, 13, 15 or 25 encoding the polypeptide of SEQ ID NO: 4, 6, 8, 10, 12, 14, 16 or 26; or the complementary strand thereof
- a polypeptide of the disclosure comprises an amino acid sequence having at least 68%, 70%, 72%, 74%, 76%, 78%, 80%%, 85%, 90%, 91 %, 92%, 93%, 94%, 95%, 96%, 97%, 98%, or 99%, sequence identity to the mature amino acid sequence of SEQ ID NO: 4, 6, 8, 10, 12, 14, 16, 17, 18 or 26.
- the disclosure is directed to a polypeptide having 90% sequence identity to the mature amino acid sequence of SEQ ID NO: 6.
- the disclosure is directed to a polypeptide having 90% sequence identity to the mature amino acid sequence of SEQ ID NO: 8.
- the disclosure is directed to a polypeptide having 96.5% sequence identity to the mature amino acid sequence of SEQ ID NO: 10.
- the disclosure is directed to a polypeptide having 96.5% sequence identity to the mature amino acid sequence of SEQ ID NO: 12.
- the disclosure is directed to a polypeptide having 96.5% sequence identity to the mature amino acid sequence of SEQ ID NO: 14.
- the disclosure is directed to a polypeptide having 90% sequence identity to the amino acid sequence of SEQ ID NO: 16.
- the disclosure is directed to a polypeptide having 90% sequence identity to the amino acid sequence of SEQ ID NO: 17.
- the disclosure is directed to a polypeptide having 90% sequence identity to the amino acid sequence of SEQ ID NO: 18.
- the disclosure is directed to a polypeptide having 90% sequence identity to the amino acid sequence of SEQ ID NO: 26.
- the disclosure is directed to a transgalactosylating polypeptide derived from Bifidobacterium bifidum. In another embodiment, the disclosure is directed to a transgalactosylating polypeptide derived from Lactobacillus delbrueckii.
- polypeptides disclosed herein have activity on carbohydrate bonds which have the ⁇ (1->4) conformation.
- This activity may be determined, for example, by utilizing synthetic substrates such as p -nitrophenol-B-D-galactopyranoside (PNPG), ortho -nitrophenol- p -D-galactopyranoside (ONPG) or ⁇ -D-galactopyranoside with chromogenic aglycons (XGal).
- PNPG p -nitrophenol-B-D-galactopyranoside
- ONPG ortho -nitrophenol- p -D-galactopyranoside
- XGal chromogenic aglycons
- a particular enzyme belongs to the EC 3.2.1.23 class of ⁇ -galactosidases is to incubate the enzyme with a substrate such as lactose, and measure the release of glucose by a method such as enzymatic determination, HPLC, TLC or other methods known to persons skilled in the art.
- a polypeptide disclosed herein has a ratio of transgalactosylating activity/galactosidase activity of at least 1, at least 2.5, at least 3, at least 4, at least 5, at least 6, at least 7, at least 8, at least 9, at least 10, at least 11, or at least 12, as measured at a concentration of 100 ppm in a milk-based assay at 37°C and 5% (w/w) lactose, after 15, 30 or 180 minutes of reaction.
- polypeptide(s) of the disclosure have a transgalactosylating activity such that more than 20%, more than 30%, more than 40%, up to 50% of the initial lactose is transgalactosylated as measured at a concentration of 100 ppm in a milk-based assay at 37°C and 5% (w/w) lactose after 15, 30 or 180 such as 180 minutes of reaction.
- the polypeptide(s) have a ⁇ -galactosidase activity such that less than 80%, less than 70%, less than 60%, less than 50%, less than 40%, less than 30%, less than 20% of the lactose has been hydrolyzed as measured at a concentration of 100 ppm in a milk-based assay at 37°C and 5% (w/w) lactose after 15, 30 or 180 such as 180 minutes of reaction.
- the ⁇ -galactosidase activity and/or the transgalactosylating activity are measured at a concentration of 100 ppm corresponding to 2.13 LAU, as specified in Method 4 of PCT International Publication No. WO2003/186286 .
- polypeptides used herein have useful transgalactosylating activity over a range of pH of 4-9, such as 5-8, such as 5.5-7.5, such as 6.5-7.5.
- a homologous sequence includes an amino acid sequence which may be at least 66%, 70%, 75%, 78%, at least 80%, at least 85%, at least 90%, at least 95%, at least 96%, at least 97%, at least 98% or at least 99%, identical to the subject sequence.
- the homologues will comprise the same active sites, etc. as the subject amino acid sequence.
- homology can also be considered in terms of similarity (i.e., amino acid residues having similar chemical properties/functions), in the context of the present disclosure it is preferred to express homology in terms of sequence identity.
- the present disclosure also encompasses the use of variants, homologues and derivatives of any amino acid sequence of a polypeptide as defined herein, particularly those of SEQ ID NO: 4, 6, 8, 10, 12, 14, 16, 17, 18 or 26.
- the transgalactosylating polypeptides of the disclosure are expressed/produced in the modified host cells of the disclosure and are substantially isolated and purified therefrom.
- such transgalactosylating polypeptides expressed/produced in the modified host cells of the disclosure and purified therefrom comprise no detectable p- nitrobenzylesterase side activity (i.e. , the purified/isolated transgalactosylating polypeptides are free of unwanted/undesirable p -nitrobenzylesterase activity).
- a particular wild-type or variant transgalactosylating polypeptide e.g. , ⁇ -galactosidase
- assays measuring the expressed protein, the corresponding mRNA, or ⁇ -galactosidase activity are readily implemented.
- suitable assays include Northern and Southern blotting, RT-PCR (reverse transcriptase polymerase chain reaction), and in situ hybridization, using an appropriately labeled hybridizing probe.
- Suitable assays also include measuring activity in a sample.
- Suitable assays of the activity of the polypeptide include, but are not limited to, ONPG based assays or determining glucose concentration in reaction mixtures.
- the polypeptides described herein for the expression/production in the modified host cells of the disclosure comprise transgalactosylation activity.
- the ratio of transgalactosylating activity/ ⁇ -galactosidase activity is at least 0.5, such as at least 1, at least 1.5, or at least 2, after 30 minutes of reaction, such as above a concentration of 3% (w/w) initial lactose concentration.
- the ⁇ -galactosidase and/or lactase polypeptides of the disclosure i.e., comprising transgalactosylating activity
- the ⁇ -galactosidase and/or lactase polypeptides are derivable from microbial sources, in particular from a filamentous fungus, yeast, or bacteria.
- the ⁇ -galactosidase and/or lactase polypeptides comprising transgalactosylating activity
- Sclerotini e.g., S. libertiana
- Torula Torulopsis
- Trichophyton e.g., T. rubrum
- Whetzelinia e.g., W. sclerotiorum
- Bacillus e.g., B. coagulans, B. circulans, B. megaterium, B. novalis, B. subtilis, B. pumilus, B. stearothermophilus, B. thuringiensis
- Bifidobacterium e.g., B. longum, B. bifidum, B.
- castaneoglobisporus S. violeceoruber
- Trichoderma e.g., T. reesei. T. viride
- Yersinia e.g., Y. enterocolitica
- ⁇ -galactosidase and/or lactase polypeptides and variants thereof can be characterized by their nucleic acid sequence and/or primary amino acid sequence, by three dimensional structural modeling, and/or by specific activity. Additional characteristics of the polypeptide or polypeptide variants as defined herein include stability, pH range, oxidation stability and thermostability. Levels of expression and enzyme activity can be assessed using standard assays known to the artisan skilled in this field.
- the introduction of a DNA construct or vector into a host cell includes techniques such as transformation, electroporation, nuclear microinjection, transduction, transfection (e.g. , lipofection mediated and DEAE-Dextrin mediated transfection), incubation with calcium phosphate DNA precipitate, high velocity bombardment with DNA-coated micro-projectiles and protoplast fusion.
- transformation electroporation, nuclear microinjection, transduction, transfection (e.g. , lipofection mediated and DEAE-Dextrin mediated transfection), incubation with calcium phosphate DNA precipitate, high velocity bombardment with DNA-coated micro-projectiles and protoplast fusion.
- General transformation techniques are well known in the art (see, e.g., Ausubel et al., 1987, Sambrook et al., 2001 and Campbell et al., 1989).
- methods known in the art may be used to select transformants.
- a transgalactosylating polypeptide composition may be prepared in accordance with methods known in the art, and may be in the form of a liquid or a dry composition.
- the polypeptide composition may be in the form of a granulate, or a microgranulate, wherein the polypeptide in the composition may be stabilized in accordance with methods well known in the art.
- the disclosure is directed to genetically modified host cells expressing/producing ⁇ -galactosidase and/or lactase enzymes, and the use of such enzymes or cells thereof for the production of galactooligosaccharide (GOS) compositions in one or more dairy related end products. More specifically, certain embodiments are directed to expressing/producing such ⁇ -galactosidase and/or lactase enzymes in modified Bacillus spp. host cells, wherein such enzymes produced and/or purified from the modified Bacillus host cells are free of unwanted/undesirable p -nitrobenzylesterase activity.
- GOS galactooligosaccharide
- Applicants of the instant disclosure have experimentally verified that a foul off-flavor smell and taste in dairy products formulated with ⁇ -galactosidase and/or lactase enzymes were caused by the unwanted/undesirable enzymatic side activity of a p -nitrobenzylesterase enzyme.
- nucleic acid sequence presented in SEQ ID NO: 1 encodes a p -nitrobenzylesterase enzyme presented in SEQ ID NO: 2, which encoded p -nitrobenzylesterase enzyme was originally identified in B. subtilis as an enzyme capable of hydrolyzing poly(ethylene terephthalate; PET), which may have specific utility in breaking down/hydrolyzing PET polymers in recycled materials ( e.g., see, Ribitsch et al., 2011).
- Example 2 deletion of the gene encoding the p -nitrobenzylesterase (SEQ ID NO: 2) in a (modified) Bacillus subtilis (daughter) host cell expressing/producing a ⁇ -galactosidase of the disclosure, completely eliminated the detectable p- nitrobenzylesterase side activity identified in ⁇ -galactosidase compositions produced by the un-modified (parental) Bacillus cells.
- a Bacillus spp. host cell of the disclosure is genetically modified to delete, disrupt or down-regulate an endogenous gene encoding a p -nitrobenzylesterase.
- a Bacillus spp. gene encoding a p -nitrobenzylesterase encodes a p -nitrobenzylesterase comprising at least about 60% to 100% amino acid sequence identity to the p -nitrobenzylesterase of SEQ ID NO: 2.
- a Bacillus spp. gene encoding a p -nitrobenzylesterase encodes a p-nitrobenzylesterase comprising at least about 70% amino acid sequence identity to the p -nitrobenzylesterase of SEQ ID NO: 2.
- a Bacillus spp. gene encoding a p -nitrobenzylesterase encodes a p -nitrobenzylesterase comprising at least about 80% amino acid sequence identity to the p- nitrobenzylesterase of SEQ ID NO: 2.
- a Bacillus spp. gene encoding a p -nitrobenzylesterase encodes a p -nitrobenzylesterase comprising about 100% amino acid sequence identity to the p -nitrobenzylesterase of SEQ ID NO: 2.
- Bacillus subtilis pnbA gene encodes a 489 amino acid p -nitrobenzylesterase (SEQ ID NO: 2, FIG. 13 ; Enzyme Commission No. 3.1.1.3) comprising a pI of about 4.8 and a molecular weight of about 53 kDa. More particularly, primary (1°) amino acid sequence analysis of the p -nitrobenzylesterase of SEQ ID NO: 2 ( e.g., see, FIG.
- catalytic apparatus involves a three residue catalytic triad comprising: serine (Ser), glutamate (Glu) or aspartate (Asp) and histidine (His), and comprises an acetyl esterase (AES) domain therein from about amino acid residue position 85 to 211 of SEQ ID NO: 2.
- a genetically modified Bacillus subtilis host cell comprises modified endogenous gene encoding a p -nitrobenzylesterase comprising at least 60% sequence identity to the p- nitrobenzylesterase of SEQ ID NO: 2, wherein the gene encoding the p -nitrobenzylesterase comprises a genetic modification which deletes, disrupts or down-regulates at least the acetyl esterase domain of the encoded p -nitrobenzylesterase.
- a genetically modified Bacillus subtilis host cell comprises a modified endogenous gene encoding a p -nitrobenzylesterase comprising at least 60% sequence identity to the p -nitrobenzylesterase of SEQ ID NO: 2, wherein the gene encoding the p- nitrobenzylesterase comprises a genetic modification which deletes, disrupts or substitutes at least one of the catalytic triad amino acids selected from serine (Ser), glutamate (Glu) or aspartate (Asp) and histidine (His).
- the gene encoding the p -nitrobenzylesterase comprises a genetic modification which deletes, disrupts or substitutes at least two of the catalytic triad amino acids selected from serine (Ser), glutamate (Glu) or aspartate (Asp) and histidine (His).
- the gene encoding the p -nitrobenzylesterase comprises a genetic modification which deletes, disrupts or substitutes all three of the catalytic triad amino acids serine (Ser), glutamate (Glu) or aspartate (Asp) and histidine (His).
- the B. subtilis p -nitrobenzylesterase of SEQ ID NO: 2 comprises a catalytic triad comprising Ser-189, Glu-310 and 399-His.
- a genetically modified Bacillus subtilis host cell comprises a modified endogenous gene encoding a p -nitrobenzylesterase comprising at least 60% sequence identity to the p- nitrobenzylesterase of SEQ ID NO: 2, wherein the gene encoding the p -nitrobenzylesterase comprises a genetic modification which deletes, disrupts or down-regulates the acetyl esterase domain of the encoded p -nitrobenzylesterase.
- a gene encoding a p -nitrobenzylesterase comprising at least 60% sequence identity to the p -nitrobenzylesterase of SEQ ID NO: 2 comprises a genetic modification which deletes, disrupts or down-regulates the acetyl esterase (AE) domain of the encoded p- nitrobenzylesterase, wherein the AE domain comprises amino acid residue positions 85 to 211 of SEQ ID NO: 2.
- AE acetyl esterase
- the AE domain of a p -nitrobenzylesterase is down-regulated by means of anti-sense RNA methodology (e.g ., an RNA molecule complementary to the endogenous gene encoding amino acid residue positions 85-211 (or a sub-sequence thereof) of p -nitrobenzylesterase), wherein the complementary RNA molecule down-regulates the expression/production of the p- nitrobenzylesterase in the modified host cell.
- the genetically modified AE domain is deleted or disrupted, wherein the modified host cell exhibits reduced or eliminated p -nitrobenzylesterase thereof.
- a genetically modified Bacillus subtilis host cell comprises a modified endogenous gene encoding a p -nitrobenzylesterase comprising at least 60% sequence identity to the p- nitrobenzylesterase of SEQ ID NO: 2, wherein the modified gene encoding the p -nitrobenzylesterase comprises a genetic modification which deletes, disrupts or down-regulates the p -nitrobenzylesterase substrate binding pocket.
- the p -nitrobenzylesterase of SEQ ID NO: 2 comprises a substrate binding pocket comprising thirteen (13) amino acid residue at positions 105-107, 188-190, 193, 326, 330, 331, 358, 400 and 403.
- amino acid residues 105-107 of SEQ ID NO: 2 comprise the motif "GGA” (G 105 ; G 106 ; A 107 ), which forms part of the substrate binding pocket.
- amino acid residues 188-193 of SEQ ID NO: 2 comprise the motif "ESAXXM” (E 188 , S 189 , A 190 , X 191 , X 192 , M 193 ; wherein X is any amino acid), which forms part of the substrate binding pocket.
- amino acid residue 326 is threonine (T 326 ), which forms part of the substrate binding pocket
- amino acid residue 330 is alanine (A 330 ), which forms part of the substrate binding pocket
- amino acid residue 331 is leucine (T 331 ), which forms part of the substrate binding pocket
- amino acid residue 358 is methionine (M 358 ), which forms part of the substrate binding pocket
- amino acid residue 400 is alanine (A 400 ), which forms part of the substrate binding pocket and amino acid residue 403 is leucine (T 403 ), which forms part of the substrate binding pocket.
- the nucleic acid sequence of SEQ ID NO: 1 (or a subsequence thereof), which encodes a Bacillus subtilis p -nitrobenzylesterase of SEQ ID NO: 2, is used to screen other Bacillus spp. host cells (e.g., B. licheniformis, B. amyloliquefaciens, and the like) for the presence of one or more genes encoding polypeptides comprising p -nitrobenzylesterase activity.
- Bacillus spp. host cells e.g., B. licheniformis, B. amyloliquefaciens, and the like
- the disclosure is directed to genetically modified Bacillus subtilis host cells comprising a deleted, disrupted or down-regulated gene encoding a p -nitrobenzylesterase comprising at least 60% sequence identity to the p -nitrobenzylesterase of SEQ ID NO: 2.
- the disclosure is directed to genetically modified Bacillus amyloliquefaciens host cells comprising a deleted, disrupted or down-regulated gene encoding a p -nitrobenzylesterase comprising about 483 to 484 amino acids and at least 62% sequence identity to the p -nitrobenzylesterase of SEQ ID NO: 2.
- the disclosure is directed to genetically modified Bacillus licheniformis host cells comprising a deleted, disrupted or down-regulated gene encoding a p -nitrobenzylesterase comprising about 490 to 492 amino acids and at least 58% sequence identity to the p -nitrobenzylesterase of SEQ ID NO: 2.
- the B. subtilis p -nitrobenzylesterase of SEQ ID NO: 2 was BLAST-P searched in the NCBI non-redundant reference sequence database ( data not shown ) , wherein more than twenty-eight (28) homologous B. subtilis p -nitrobenzylesterase proteins were identified with sequence identities to SEQ ID NO: 2 ranging from 100% to about 80%.
- more than ten (10) homologous B. amyloliquefaciens p -nitrobenzylesterase proteins were identified with sequence identities to SEQ ID NO: 2 ranging from 62% to about 65% and wherein the encoded p -nitrobenzylesterase comprises about 483 to 484 amino acids.
- more than eight (8) B. licheniformis p- nitrobenzylesterase proteins were identified with sequence identities to SEQ ID NO: 2 ranging from 60% to about 65% and wherein the encoded p- nitrobenzylesterase comprises about 490 to 492 amino acids.
- certain embodiments of the disclosure are directed to modified Bacillus sp. host cells comprising a deleted, disrupted or down-regulated p -nitrobenzylesterase protein comprising at least 60% sequence identity to the p -nitrobenzylesterase amino acid sequence of SEQ ID NO: 2.
- Related embodiments are therefore directed to expressing/producing ⁇ -galactosidases and/or lactases in the modified Bacillus host cells of the disclosure, wherein the ⁇ -galactosidases and/or lactases expressed/produced therefrom are free of detectable p -nitrobenzylesterase activity, thereby eliminating the foul off-flavor smells and tastes observed with dairy products contaminated with such p -nitrobenzylesterase side activity.
- certain embodiments of the disclosure are directed to genetically modified Bacillus host cells capable of expressing/producing one or more ⁇ -galactosidases and/or lactases of the disclosure.
- International PCT Publication No. WO2016/071504 discloses recombinant Bacillus subtilis host cells transformed with polynucleotide constructs ( e.g. , expression constructs) encoding various ⁇ -galactosidases.
- Bacillus host cells are well known in the art as expression hosts and are particularly suitable host cells for expressing/producing one or more ⁇ -galactosidases and/or lactases of the disclosure.
- the disclosure is therefore directed to methods for genetically modifying Bacillus cells, wherein the modification comprises (a) the introduction, substitution, or removal of one or more nucleotides in a gene (or an ORF thereof), or the introduction, substitution, or removal of one or more nucleotides in a regulatory element required for the transcription or translation of the gene or ORF thereof, (b) a gene disruption, (c) a gene conversion, (d) a gene deletion, (e) a gene down-regulation, (f) site specific mutagenesis and/or (g) random mutagenesis.
- the modification comprises (a) the introduction, substitution, or removal of one or more nucleotides in a gene (or an ORF thereof), or the introduction, substitution, or removal of one or more nucleotides in a regulatory element required for the transcription or translation of the gene or ORF thereof, (b) a gene disruption, (c) a gene conversion, (d) a gene deletion, (e) a gene down-regulation, (f) site specific
- a modified Bacillus cell of the disclosure is constructed by reducing or eliminating the expression of a p -nitrobenzylesterase gene set forth above, using methods well known in the art, for example, insertions, disruptions, replacements, deletions, truncations, substitutions, frame shift mutations and the like.
- the portion of the p -nitrobenzylesterase gene to be modified or inactivated may be, for example, the coding region or a regulatory/control element required for expression of the coding region.
- An example of such a regulatory or control sequence may be a promoter sequence or a functional part thereof, ( i.e. , a part which is sufficient for affecting expression of the nucleic acid sequence).
- Other control sequences for modification include, but are not limited to, a leader sequence, a pro-peptide sequence, a signal sequence, a transcription terminator, a transcriptional activator and the like.
- a modified Bacillus cell is constructed by gene deletion to eliminate or reduce the expression of the p -nitrobenzylesterase gene.
- Gene deletion techniques enable the partial or complete removal of the gene(s), thereby eliminating their expression, or expressing a non-functional (or reduced activity) protein product.
- the deletion of the gene may be accomplished by homologous recombination using a plasmid that has been constructed to contiguously contain the 5' and 3' regions flanking the gene.
- the contiguous 5' and 3' regions may be introduced into a Bacillus cell, for example, on a temperature-sensitive plasmid, such as pE194, in association with a second selectable marker at a permissive temperature to allow the plasmid to become established in the cell.
- the cell is then shifted to a non-permissive temperature to select for cells that have the plasmid integrated into the chromosome at one of the homologous flanking regions.
- Selection for integration of the plasmid is effected by selection for the second selectable marker.
- a recombination event at the second homologous flanking region is stimulated by shifting the cells to the permissive temperature for several generations without selection.
- the cells are plated to obtain single colonies and the colonies are examined for loss of both selectable markers (see, e.g., Perego, 1993).
- a person of skill in the art e.g., by reference to the p -nitrobenzylesterase gene's (nucleic acid) sequence and the encoded protein sequence thereof, may readily identify nucleotide regions in the gene's coding sequence and/or the gene's non-coding sequence suitable for complete or partial deletion.
- a modified Bacillus cell of the disclosure is constructed by introducing, substituting, or removing one or more nucleotides in the gene or a regulatory element required for the p- nitrobenzylesterase transcription or translation thereof.
- nucleotides may be inserted or removed so as to result in the introduction of a stop codon, the removal of the start codon, or a frame-shift of the open reading frame.
- Such a modification may be accomplished by site-directed mutagenesis or PCR generated mutagenesis in accordance with methods known in the art (e.g., see, Botstein and Shortle, 1985; Lo et al., 1985; Higuchi et al., 1988; Shimada, 1996; Ho et al., 1989; Horton et al., 1989 and Sarkar and Sommer, 1990).
- a p -nitrobenzylesterase gene of the disclosure is inactivated by complete or partial deletion.
- a modified Bacillus cell is constructed by the process of gene conversion (e.g., see Iglesias and Trautner, 1983).
- gene conversion e.g., see Iglesias and Trautner, 1983.
- a nucleic acid sequence corresponding to the gene is mutagenized in vitro to produce a defective nucleic acid sequence, which is then transformed into the parental Bacillus cell to produce a defective gene.
- the defective nucleic acid sequence replaces the endogenous gene.
- the defective gene or gene fragment also encodes a marker which may be used for selection of transformants containing the defective gene.
- the defective gene may be introduced on a non-replicating or temperature-sensitive plasmid in association with a selectable marker.
- Selection for integration of the plasmid is effected by selection for the marker under conditions not permitting plasmid replication.
- Selection for a second recombination event leading to gene replacement is effected by examination of colonies for loss of the selectable marker and acquisition of the mutated gene (Perego, 1993).
- the defective nucleic acid sequence may contain an insertion, substitution, or deletion of one or more nucleotides of the gene, as described below.
- a modified Bacillus cell is constructed by established anti-sense techniques using a nucleotide sequence complementary to the nucleic acid sequence of the p -nitrobenzylesterase gene (Parish and Stoker, 1997). More specifically, expression of the p -nitrobenzylesterase gene by a Bacillus cell may be reduced (down-regulated) or eliminated by introducing a nucleotide sequence complementary to the nucleic acid sequence of the p -nitrobenzylesterase gene, which may be transcribed in the cell and is capable of hybridizing to the p -nitrobenzylesterase mRNA produced in the cell.
- RNA interference RNA interference
- siRNA small interfering RNA
- miRNA microRNA
- antisense oligonucleotides antisense oligonucleotides
- a modified Bacillus cell is produced/constructed via CRISPR-Cas9 editing.
- a gene encoding p -nitrobenzylesterase can be disrupted (or deleted or down-regulated) by means of nucleic acid guided endonucleases, that find their target DNA by binding either a guide RNA ( e.g., Cas9) and Cpf1 or a guide DNA ( e.g., NgAgo), which recruits the endonuclease to the target sequence on the DNA, wherein the endonuclease can generate a single or double stranded break in the DNA.
- a guide RNA e.g., Cas9
- Cpf1 e.g., Cpf1
- a guide DNA e.g., NgAgo
- This targeted DNA break becomes a substrate for DNA repair, and can recombine with a provided editing template to disrupt or delete the gene.
- the gene encoding the nucleic acid guided endonuclease for this purpose Cas9 from S . pyogenes
- a codon optimized gene encoding the Cas9 nuclease is operably linked to a promoter active in the Bacillus cell and a terminator active in Bacillus cell, thereby creating a Bacillus Cas9 expression cassette.
- one or more target sites unique to the p- nitrobenzylesterase gene are readily identified by a person skilled in the art.
- variable targeting (VT) domain will comprise nucleotides of the target site which are 5' of the (PAM) proto-spacer adjacent motif (TGG), which nucleotides are fused to DNA encoding the Cas9 endonuclease recognition domain for S . pyogenes Cas9 (CER).
- PAM proto-spacer adjacent motif
- CER pyogenes Cas9
- the combination of the DNA encoding a VT domain and the DNA encoding the CER domain thereby generate a DNA encoding a gRNA.
- a Bacillus expression cassette for the gRNA is created by operably linking the DNA encoding the gRNA to a promoter active in Bacillus cells and a terminator active in Bacillus cells.
- a modified Bacillus cell is constructed by random or specific mutagenesis using methods well known in the art, including, but not limited to, chemical mutagenesis ( see, e.g., Hopwood, 1970) and transposition (see, e.g., Youngman et al., 1983). Modification of the gene may be performed by subjecting the parental cell to mutagenesis and screening for mutant cells in which expression of the p -nitrobenzylesterase gene has been reduced or eliminated.
- the mutagenesis which may be specific or random, may be performed, for example, by use of a suitable physical or chemical mutagenizing agent, use of a suitable oligonucleotide, or subjecting the DNA sequence to PCR generated mutagenesis.
- the mutagenesis may be performed by use of any combination of these mutagenizing methods.
- Examples of a physical or chemical mutagenizing agent suitable for the present purpose include ultraviolet (UV) irradiation, hydroxylamine, N-methyl-N'-nitro-N-nitrosoguanidine (MNNG), N-methyl-N'-nitrosoguanidine (NTG), O-methyl hydroxylamine, nitrous acid, ethyl methane sulphonate (EMS), sodium bisulphite, formic acid, and nucleotide analogues.
- UV ultraviolet
- MNNG N-methyl-N'-nitro-N-nitrosoguanidine
- NTG N-methyl-N'-nitrosoguanidine
- EMS ethyl methane sulphonate
- sodium bisulphite formic acid
- nucleotide analogues examples include ultraviolet (UV) irradiation, hydroxylamine, N-methyl-N'-nitro-N-nitrosoguanidine (MNNG), N-methyl-N'-nitrosoguanidine
- a modified Bacillus cell comprises a disruption of an endogenous p- nitrobenzylesterase gene, wherein the polynucleotide disruption cassette comprises a marker gene.
- PCT Publication No. WO2003/083125 discloses methods for modifying Bacillus cells, such as the creation of Bacillus deletion strains and DNA constructs using PCR fusion to bypass E . coli.
- PCT Publication No. WO2002/14490 discloses methods for modifying Bacillus cells including (1) the construction and transformation of an integrative plasmid (p ComK ), (2) random mutagenesis of coding sequences, signal sequences and pro-peptide sequences, (3) homologous recombination, (4) increasing transformation efficiency by adding non-homologous flanks to the transformation DNA, (5) optimizing double cross-over integrations, (6) site directed mutagenesis and (7) marker-less deletion.
- p ComK integrative plasmid
- host cells are directly transformed (i.e., an intermediate cell is not used to amplify, or otherwise process, the DNA construct prior to introduction into the host cell).
- Introduction of the DNA construct into the host cell includes those physical and chemical methods known in the art to introduce DNA into a host cell, without insertion into a plasmid or vector. Such methods include, but are not limited to, calcium chloride precipitation, electroporation, naked DNA, liposomes and the like.
- DNA constructs are co-transformed with a plasmid without being inserted into the plasmid.
- a selective marker is deleted or substantially excised from the modified Bacillus strain by methods known in the art (e.g., Stahl et al., 1984 and Palmeros et al., 2000).
- resolution of the vector from a host chromosome leaves the flanking regions in the chromosome, while removing the indigenous chromosomal region.
- a suitable Bacillus host cell of the disclosure includes, but is not limited to, Bacillus subtilis, B. licheniformis, B. lentus, B. brevis, B. stearothermophilus, B. alkalophilus, B. amyloliquefaciens, B. coagulans, B. circulans. B. lautus and B. thuringiensis.
- the Bacillus host cell is a B. subtilis host cell, a B. licheniformis host cell or a B. amyloliquefaciens host cell.
- expressing/producing such ⁇ -galactosidase and/or lactase enzymes in genetically modified Bacillus host cells i.e., Bacillus host cells comprising a deletion, disruption or down-regulation of a gene encoding a p -nitrobenzylesterase
- Bacillus host cells comprising a deletion, disruption or down-regulation of a gene encoding a p -nitrobenzylesterase
- enzymes produced and purified from the modified Bacillus host cells are free of unwanted/undesirable enzymatic side activities including, but not limited to, unwanted/undesirable p -nitrobenzylesterase side activity, unwanted/undesirable lipase side activities, phospholipase side activities, cellulase side activities, pectinase side activities, amylase side activities, protease side activities, mannanase side activities and the like.
- the disclosure is directed to genetically modified Bacillus host cells comprising a deletion, disruption or down-regulation of a gene encoding at least one additional unwanted/undesirable enzymatic activity selected from a cellulase, a mannanase, a pectinase, an amylase, a protease, a lipase and/or a phospholipase side activity.
- modified Bacillus host cells in which these enzymes are essentially inactive may be obtained by genetic modification using recombinant genetic manipulation techniques as generally set forth above with respect to the p -nitrobenzylesterase activity.
- Modification of the genes coding for a cellulase, a mannanase, a pectinase, an amylase, a protease, a lipase, and/or a phospholipase can be generated by subjecting the parent Bacillus cell to mutagenesis and selecting for mutant Bacillus cells in which the ability to express these enzymes has been reduced by direct comparison to the parental Bacillus cell.
- the mutagenesis which may be specific or random, may be performed, for example, by use of a suitable physical or chemical mutagenizing agent, by use of a suitable oligonucleotide, by use of CRSIPR/Cas9 editing, or by subjecting the DNA sequence to PCR-generated mutagenesis. Furthermore, the mutagenesis may be performed by use of any combination of these mutagenizing agents.
- the cellulase, mannanase, pectinase, amylase, protease, lipase, and/or phospholipase deficient host cell may be selected by monitoring the expression level of the enzyme(s).
- the cellulase, mannanase, pectinase, amylase, protease, lipase and/or phospholipase deficient host cell may be subsequently selected by measuring the expression level of a given gene of interest to be expressed (e.g ., a ⁇ -galactosidase/lactase enzyme of the disclosure) in the host cell. Selection of host cells having reduced enzyme activity may be done by directly measuring the enzyme activity in culture broth, in culture supernatant, in permeabilized cells, or cell lysate.
- host cells that have a reduced amount of lipase, phospholipase, cellulase, pectinase, amylase, protease, mannanase side activities (or a host cell in which these enzymes are essentially inactive) may be constructed using recombinant DNA technology.
- lipase, phospholipase, cellulase, pectinase, amylase, protease and/or mannanase activity by altering the control sequence(s) directing the expression of the lipase, phospholipase, cellulase, pectinase, amylase, protease and/or mannanase gene are part of the present invention.
- methods such as gene disruption are readily available and useful for lowering or eliminating promoter activity.
- the genome of a host cell of the disclosure is modified to be deficient in lipase, phospholipase, cellulase, pectinase, amylase, protease and/or mannanase activity (e.g ., by inserting a "marker gene" into a gene coding for the enzyme activity).
- the inserted marker gene replaces part of the gene coding for the enzyme from the genome ( e.g., 25%, 50% or 75% of the gene) or all of the gene coding for the enzyme from the genome.
- RNA interference FEMS Microb. Lett. 237:317-324, 2004 ).
- expression of the gene by a Bacillus host cell may be reduced or eliminated by cloning identical sense and antisense portions of the nucleotide sequence, which expression is to be affected, behind each other with a nucleotide spacer in between, inserting into an expression vector, and introducing the expression vector into the cell where double-stranded RNA (dsRNA) may be transcribed and then processed to shorter siRNA that is able to hybridize to target mRNA. After dsRNA is transcribed, formation of small (21-23) nucleotide siRNA fragments will lead to a targeted degradation of the mRNA, which is to be affected. The elimination of the specific mRNA can be to various extents.
- RNA interference techniques described in PCT Publication NOs: WO 2005/05672 and WO 2005/026356 may be used for modification of the host gene.
- a modified host cell of the disclosure comprising decreased lipase, phospholipase, cellulase, pectinase, amylase, protease and/or mannanase activity is constructed by classical genetic techniques or recombinant DNA technology.
- these modified host cells are used for the production of the industrially relevant enzymes having transgalactosylating activity. More preferably these modified host cells are used for the production of enzymes that are used in the food industry, even more preferably these enzymes are used in processing of dairy products.
- Such industrial production host cells with decreased lipase, phospholipase, cellulase, pectinase, amylase, protease and/or mannanase activity are used for the production of galactooligosaccharides (GOS) from lactose substrates.
- GOS galactooligosaccharides
- the lipase, phospholipase, cellulase, pectinase, amylase, protease and/or mannanase deficient host cells of the invention are modified host cells having less than 50% of the detectable intracellular or extracellular lipase, phospholipase, cellulase, pectinase, amylase, protease and/or mannanase activity as generally described in International PCT Publication No. WO2016/071504 .
- the lipase, phospholipase, cellulase, pectinase, amylase, protease and/or mannanase deficient host cells of the disclosure are modified host cells having less than 50% of the lipase, phospholipase, cellulase, pectinase, amylase, protease and/or mannanase activity.
- the lipase, phospholipase, cellulase, pectinase, amylase, protease and/or mannanase deficient host cells of the disclosure are modified host cells having lipase, phospholipase, cellulase, pectinase, amylase, protease and/or mannanase activity, which is less than 25% of the lipase, phospholipase, cellulase, pectinase, amylase, protease and/or mannanase activity of the unmodified (parental) host cell.
- less than 10%, more preferably less than 5%, more preferably less than 1 % and most preferably the lipase, phospholipase, cellulase, pectinase, amylase, protease and/or mannanase activity is undetectable in the deficient ( i.e., genetically modified) host cells of the invention.
- Detection systems include any possible assay for detection of polypeptide or enzymatic activity.
- these assay systems include, but are not limited to, assays based on colorimetric, photometric, fluorometric, turbidimetric, viscosimetric, immunological, biological, chromatographic and other available assays.
- the amount of active enzyme produced e.g ., an active lipase, phospholipase, cellulase, pectinase, amylase, protease and/or mannanase) is determined by measurement of its activity in a model reaction.
- the lipase, phospholipase, cellulase, pectinase, amylase, protease and/or mannanase deficient ( i.e., modified) host cell of the disclosure is characterized by the fact that when modified host cell has been transformed with an expression construct comprising a gene coding for a polypeptide having transgalactosylating activity, the modified host cell produces at least the same amount of the polypeptide that the unmodified (parental) host cell produces under the same culture conditions, when the unmodified (parental) host cell has also been transformed with the same expression construct as the lipase, phospholipase, cellulase, pectinase, amylase, protease and/or mannanase deficient modified host cell.
- lipase, phospholipase, cellulase, pectinase, amylase, protease and/or mannanase deficient host cells of the disclosure are modified host cells that produce the same amount or more of the polypeptide having transgalactosylating activity than the unmodified (parental) host cell under the same culture conditions.
- the lipase, phospholipase, cellulase, pectinase, amylase, protease and/or mannanase deficient host cells produce more of a given polypeptide than the unmodified (parental) host cell under the same culture conditions.
- the present disclosure describes isolated polypeptides having transgalactosylating activity, as described above, which are encoded by polynucleotides which hybridize under very low stringency conditions, preferably low stringency conditions, more preferably medium stringency conditions, more preferably medium-high stringency conditions, even more preferably high stringency conditions, and most preferably very high stringency conditions with (i) a nucleic acid sequence comprised in SEQ ID NO: 3, 5, 7, 9, 11, 13, 15 or 25, encoding a mature polypeptide of SEQ ID NO: 4, 6, 8, 10, 12, 15, 16 or 26, (ii) the cDNA sequence of (i), or (iii) the complementary strand of (i) or (ii).
- a subsequence of SEQ ID NO: 3, 5, 7, 9, 11, 13, 15 or 25 contains at least 100 contiguous nucleotides, or at least 200 contiguous nucleotides.
- the subsequence may encode a polypeptide fragment which has lactase or transgalactosylase activity.
- nucleotide sequence of SEQ ID NO: 3, 5, 7, 9, 11, 13, 15 or 25 (or a subsequence thereof), as well as the amino acid sequence of SEQ ID NO: 4, 6, 8, 10, 12, 14, 16 or 26 (or a fragment thereof), may be used to design a nucleic acid probe to identify and clone DNA encoding polypeptides having transgalactosylase activity from strains of different genera or species, according to methods well known in the art.
- probes can be used for hybridization with the genomic or cDNA of the genus or species of interest, following standard Southern blotting procedures, in order to identify and isolate the corresponding gene therein.
- Such probes can be considerably shorter than the entire sequence, but should be at least 14, preferably at least 25, more preferably at least 35, and most preferably at least 70 nucleotides in length. It is, however, preferred that the nucleic acid probe is at least 100 nucleotides in length.
- a nucleic acid probe may be at least 200 nucleotides, preferably at least 300 nucleotides, more preferably at least 400 nucleotides, or most preferably at least 500 nucleotides in length. Even longer probes may be used ( e.g.
- nucleic acid probes which are at least 600 nucleotides, at least preferably at least 700 nucleotides, more preferably at least 800 nucleotides, or most preferably at least 900 nucleotides in length). Both DNA and RNA probes can be used.
- the probes are typically labeled for detecting the corresponding gene (for example, with 32P, 3H, 35S, biotin, or avidin). Such probes are encompassed by the present invention.
- a genomic DNA library prepared from such organisms may, therefore, be screened for DNA which hybridizes with the probes described above and which encodes a polypeptide having lactase activity.
- Genomic or other DNA from such other organisms may be separated by agarose or polyacrylamide gel electrophoresis, or other separation techniques.
- DNA from the libraries or the separated DNA may be transferred to and immobilized on nitrocellulose or other suitable carrier material.
- the carrier material is used in a Southern blot.
- hybridization indicates that the nucleotide sequence hybridizes to a labelled nucleic acid probe corresponding to the nucleotide sequence shown in SEQ ID NO: 3, 5, 7, 9, 11, 13 or 15, its complementary strand, or a subsequence thereof, under very low to very high stringency conditions. Molecules to which the nucleic acid probe hybridizes under these conditions can be detected using X-ray film.
- the nucleic acid probe may be the mature polypeptide coding region of SEQ ID NO: 3, 5, 7, 9, 11, 13, 15 or 25.
- very low to very high stringency conditions are defined as pre-hybridization and hybridization at 42°C in 5X SSPE, 0.3% SDS, 200 g/ml sheared and denatured salmon sperm DNA, and either 25% formamide (for very low and low stringencies), 35% formamide (for medium and medium-high stringencies), or 50% formamide (for high and very high stringencies), following standard Southern blotting procedures for 12 to 24 hours optimally.
- the carrier material is finally washed three times each for 15 minutes using 2X SSC, 0.2% SDS preferably at least at 45°C (very low stringency), more preferably at least at 50°C (low stringency), more preferably at least at 55°C (medium stringency), more preferably at least at 60°C (medium-high stringency), even more preferably at least at 65°C (high stringency), and most preferably at least at 70°C (very high stringency).
- the wash is conducted using 0.2 SSC, 0.2% SDS preferably at least at 45°C (very low stringency), more preferably at least at 50°C (low stringency), more preferably at least at 55°C (medium stringency), more preferably at least at 60°C (medium-high stringency), even more preferably at least at 65°C (high stringency), and most preferably at least at 70°C (very high stringency).
- stringency conditions are defined as pre-hybridization, hybridization, and washing post-hybridization at about 5°C to about 10°C below the calculated T m using the calculation according to Bolton and McCarthy (1962, Proceedings of the National Academy of Sciences USA 48:1390 ) in 0.9 M NaCI, 0.09 M Tris-HCI (pH 7.6), 6 mM EDTA, 0.5% NP-40, 1X Denhardt's solution, 1 mM sodium pyrophosphate, 1 mM sodium monobasic phosphate, 0.1 mM ATP and 0.2 mg of yeast RNA per ml following standard Southern blotting procedures.
- the carrier material is washed once in 6X SCC plus 0.1 % SDS for 15 minutes and twice each for 15 minutes using 6X SSC at 5°C to 10°C below the calculated T m .
- the effective T m is what controls the degree of identity required between the probe and the filter bound DNA for successful hybridization.
- the effective T m may be determined using the formula below to determine the degree of identity required for two DNAs to hybridize under various stringency conditions.
- variant nucleic acids of the disclosure include a polynucleotide having a certain percent (e.g. , 60%, 65%, 70%, 75%, 80%, 85%, 90%, 95%, or 99%) of sequence identity with the nucleic acid encoding SEQ ID NO: 4, 6, 8, 10, 12, 15, 16 or 26.
- a nucleic acid capable of encoding a polypeptide as disclosed herein is provided.
- the herein disclosed nucleic acid has a nucleic acid sequence which is at least 60%, such as at least 65%, such as at least 70%, such as at least 75%, such as at least 80%, such as at least 85%, such as at least 90%, such as at least 95%, such as at least 99% identical SEQ ID NO: 3, 5, 7, 9, 11, 13, 15 or 25.
- the disclosure provides a plasmid comprising a nucleic acid encoding a ⁇ -galactosidase and/or lactase polypeptide of the disclosure. In certain other embodiments, the disclosure provides an expression vector comprising a nucleic acid encoding a ⁇ -galactosidase and/or lactase polypeptide of the disclosure.
- the ⁇ -galactosidase and/or lactase polypeptides (and variants thereof) described herein are produced through recombinant expression in a host cell according to procedures well known in the art. More particularly, in certain embodiments the ⁇ -galactosidase and/or lactase polypeptides (and variants thereof) as described herein are expressed/produced in a modified Bacillus host cell comprising at least a disruption or deletion of a gene encoding a p -nitrobenzylesterase comprising at least 60% sequence identity to SEQ IDNO: 2.
- the instant disclosure is directed to one or more vectors comprising a polynucleotide encoding a protein of interest.
- proteins of interest include ⁇ -galactosidase/lactase polypeptides, such as the ⁇ -galactosidase/lactase polypeptides set forth as SEQ ID NOs: 4, 6, 8, 10, 12, 14, 16, 17, 18 or 26.
- a recombinant host cell of the disclosure comprises one or more vectors introduced therein.
- a polynucleotide/DNA construct encoding a ⁇ -galactosidase/lactase polypeptide of the disclosure is introduced into a host cell as an "expression vector", which vector comprises regulatory sequences (e.g. , a promoter sequence, a terminator sequence, 5'UTRs, 3'UTRs and the like) operably linked to the ⁇ -galactosidase and/or lactase encoding sequence.
- regulatory sequences e.g. , a promoter sequence, a terminator sequence, 5'UTRs, 3'UTRs and the like
- an expression vector comprising a nucleic acid sequence encoding a ⁇ -galactosidase/lactase polypeptide of the disclosure is introduced into a genetically modified host cell (e.g., a Bacillus cell), which genetically modified host cell comprises at least a deletion, disruption or down-regulation of a gene encoding a p -nitrobenzylesterase comprising at least 60% sequence identity to SEQ IDNO: 2.
- a genetically modified host cell e.g., a Bacillus cell
- which genetically modified host cell comprises at least a deletion, disruption or down-regulation of a gene encoding a p -nitrobenzylesterase comprising at least 60% sequence identity to SEQ IDNO: 2.
- Exemplary vectors include, but are not limited to, pBR322 and pUC19, which permit replication in E. coli, and pE194, which permits replication in Bacillus.
- a nucleic acid encoding a ⁇ -galactosidase/lactase polypeptide of the disclosure is operably linked to a suitable promoter, which allows transcription in the host cell.
- the promoter may be derived from genes encoding proteins either homologous or heterologous to the host cell. Promoters and promoter sequence regions for use in the expression of genes, open reading frames (ORFs) thereof and/or variant sequences thereof in Bacillus cells are generally known to one of skill in the art. Promoter sequences of the disclosure are generally chosen so that they are functional in the Bacillus cells (e.g., B. licheniformis cells, B. subtilis cells and the like).
- Bacillus promoter sequences include, but are not limited to, the B. subtilis alkaline protease ( aprE ) promoter, the ⁇ -amylase promoter of B. subtilis, the ⁇ -amylase promoter of B. amyloliquefaciens, the neutral protease ( nprE ) promoter from B. subtilis, a mutant aprE promoter ( PCT Publication No. WO2001/51643 ) or any other promoter from a related Bacilli.
- the promoter is a ribosomal protein promoter or a ribosomal RNA promoter (e.g., the rrnI promoter) disclosed in U.S.
- Patent Publication No. 2014/0329309 Methods for screening and creating promoter libraries with a range of activities (promoter strength) in Bacillus cells is describe in PCT Publication No. WO2003/089604 .
- the promoter is native to the Bacillus host cell, whereas in other embodiments the promoter is heterologous (foreign) to the Bacillus host cell.
- a polynucleotide sequence (e.g ., comprised in a vector/expression construct) encoding a ⁇ -galactosidase/lactase polypeptide is operably linked to a nucleic acid sequence encoding a signal sequence (signal peptide).
- a nucleic acid sequence encoding a signal sequence is derived B. bifidum or a Bacillus spp.
- the native signal sequence of B. subtilis aprE is used, or alternatively, a nucleotide sequence encoding a signal sequence from other Bacillus spp. secreted proteins.
- the polynucleotide sequence that encodes the signal sequence is place immediately upstream (5') and in-frame of the polynucleotide ( i.e., operably linked) that encodes the ⁇ -galactosidase/lactase polypeptide of the disclosure.
- the disclosure includes a signal sequence and a promoter sequence which are comprised in the vector to be introduced into the host cell.
- the expression vector also includes a termination sequence.
- the termination sequence, the signal sequence and the promoter sequence are derived from the same source or different sources.
- an expression vector includes a selectable marker.
- selectable markers include those that confer resistance to antimicrobial agents (e.g ., hygromycin, phleomycin and the like) and nutritional selective (auxotrophic) markers.
- a suitable expression vector comprising a DNA construct encoding a ⁇ -galactosidase/lactase polypeptide of the disclosure may be any vector that is capable of replicating autonomously in a Bacillus host cell, or integrating into the genome of the host cell.
- the present disclosure is directed to methods of transcribing a nucleotide sequence in a modified host cell deficient in (unwanted/undesirable) para -nitrobenzylesterase activity.
- the present disclosure is directed to methods of transcribing a nucleotide sequence in a modified host cell deficient in para -nitrobenzylesterase activity, wherein the modified host cell is further engineered to be deficient is at least one additional (unwanted/undesirable) enzymatic activity selected from lipase, phospholipase, cellulase, pectinase, amylase, protease and/or mannanase activity, wherein the transcribed sequence encodes the polypeptide having transgalactosylating activity comprising cultivating, in a culture medium, the modified host cell of the disclosure comprising an expression construct encoding a transgalactosylating polypeptide of the disclosure.
- a modified host cell deficient in para-nitrobenzylesterase activity is (1) transformed with an expression construct comprising (a) a 5' promoter region upstream and operably linked to (b) a downstream nucleotide sequence (e.g. , an ORF) which encodes a transgalactosylating polypeptide of the disclosure and (c) a translational stop signal which is 3' and operably linked to nucleic acid sequence encoding the transgalactosylating polypeptide and (2) expressing the transgalactosylating polypeptide in the modified host cell.
- the transgalactosylating polypeptide expressed/produced in the modified host cell of the disclosure is recovered from the culture medium or from the modified host cell ( e.g., via cell lysis).
- the modified host cells deficient in deficient para -nitrobenzylesterase, lipase, phospholipase, cellulase, pectinase, amylase, protease and/or mannanase are produced according to the methods of the present disclosure.
- the deficient (modified) host cells are be grown or maintained in a nutrient medium suitable for production of the desired polypeptide using methods known in the art.
- cells may be plated on a solid substrate, shaken in a flask, cultivated in small-scale or large-scale fermentation (including continuous, batch, fed-batch, or solid-state fermentation) in laboratory or industrial fermenters in a suitable medium and under conditions allowing the polypeptide to be expressed and/or isolated.
- Cultivation takes place in a suitable nutrient medium comprising carbon and nitrogen sources and inorganic salts, using procedures known in the art. Suitable media are available from commercial suppliers or may be prepared using published compositions ( e.g. , in catalogues of the American Type Culture Collection). If the polypeptide is secreted into the nutrient medium, the polypeptide can be recovered directly from the medium. If the polypeptide is not secreted, it can be recovered from cell lysates.
- polypeptide(s) may be isolated by methods known in the art.
- the polypeptide may be isolated from the nutrient medium by conventional procedures including, but not limited to, centrifugation, filtration, extraction, spray drying, evaporation, or precipitation.
- the isolated polypeptide may then be further purified by a variety of procedures well known in the art including, but not limited to, chromatography (e.g ., ion exchange, affinity, hydrophobic, chromatofocusing or size exclusion), electrophoresis (e.g., preparative isoelectric focusing), differential solubility (e.g., acetone or ammonium sulfate precipitation), or extraction (e.g ., chaotrope, salt, or pH).
- chromatography e.g ., ion exchange, affinity, hydrophobic, chromatofocusing or size exclusion
- electrophoresis e.g., preparative isoelectric focusing
- differential solubility e.g., acetone or ammonium sulfate precipitation
- extraction e.g ., chaotrope, salt, or pH.
- the polypeptide may be detected using methods known in the art that are specific for a polypeptide having transgalactosylating activity. These detection methods may include use of specific antibodies, formation of an enzyme product, disappearance of an enzyme substrate, or SDS-PAGE. For example, an enzyme assay may be used to determine the activity of the polypeptide. Procedures for determining enzyme activity are known in the art for many enzymes. More particularly, the disclosures of International PCT Publications NOs: WO2016/071504 and WO2015/086746 , provide specific methods and compositions thereof for assaying polypeptide having transgalactosylating activity (e.g ., ⁇ -galactosidases/lactases).
- a polypeptide having transgalactosylating activity i.e., as produced in a modified host cell of the disclosure is assayed according to the methods and compositions set forth in International PCT Publications NOs: WO2016/071504 and WO2015/086746 .
- the disclosure is directed to compositions and methods for expressing a transgalactosylating polypeptide as described herein, comprising obtaining a modified host cell of the disclosure (i.e., comprising at least a deletion, disruption or down-regulation of a gene encoding a para -nitrobenzylesterase), and expressing the transgalactosylating polypeptide in the modified host cell, and optionally purifying the transgalactosylating polypeptide.
- a modified host cell of the disclosure i.e., comprising at least a deletion, disruption or down-regulation of a gene encoding a para -nitrobenzylesterase
- transgalactosylating polypeptides expressed/produced in the modified host cells of the disclosure are free of detectable para- nitrobenzylesterase activity, and as such, are particularly useful in the generation of galactooligosaccharide (GOS) compositions via lactose substrates.
- GOS galactooligosaccharide
- the expression/production of one or more transgalactosylating polypeptides in the modified host cells of the disclosure i.e., comprising a deletion, disruption or down-regulation of the gene encoding the para- nitrobenzylesterase of SEQ ID NO: 2) produce such transgalactosylating polypeptides in the absence of the contaminating para -nitrobenzylesterase side activity, thereby eliminating the foul off-flavor tastes and smells detected when using such transgalactosylating polypeptides which are expressed/produced in unmodified (parental) host cells comprising the para- nitrobenzylesterase side activity.
- the modified host cells of the disclosure are further modified to be deficient in at least one additional unwanted/undesirable enzymatic side activity selected from lipase, phospholipase, cellulase, pectinase, amylase, protease and/or mannanase ( e.g., see, WO2016/071504 ).
- the introduction of an expression construct or vector into a host cell includes techniques such as transformation, electroporation, nuclear microinjection, transduction, transfection (e.g. , lipofection mediated and DEAE-Dextrin mediated transfection), incubation with calcium phosphate DNA precipitate, high velocity bombardment with DNA-coated micro-projectiles and protoplast fusion.
- General transformation techniques are well known in the art (see, e.g., Ausubel et al., 1987, Sambrook et al., 2001, and Campbell et al., Curr. Genet. 16: 53-56 (1989 ).
- methods known in the art may be used to select transformants.
- the instant disclosure is directed to methods of producing transgalactosylating polypeptides in a modified host cell, comprising fermenting/cultivating the modified host cell. Fermentation methods well known in the art can be applied to ferment the modified (daughter) and unmodified (parental) Bacillus cells of the disclosure.
- the cells are cultured under batch or continuous fermentation conditions.
- a classical batch fermentation is a closed system, where the composition of the medium is set at the beginning of the fermentation and is not altered during the fermentation. At the beginning of the fermentation, the medium is inoculated with the desired organism(s). In this method, fermentation is permitted to occur without the addition of any components to the system.
- a batch fermentation qualifies as a "batch” with respect to the addition of the carbon source, and attempts are often made to control factors such as pH and oxygen concentration.
- the metabolite and biomass compositions of the batch system change constantly up to the time the fermentation is stopped.
- cells can progress through a static lag phase to a high growth log phase, and finally to a stationary phase, where growth rate is diminished or halted. If untreated, cells in the stationary phase eventually die.
- cells in log phase are responsible for the bulk of production of product.
- a suitable variation on the standard batch system is the "fed-batch fermentation" system.
- the substrate is added in increments as the fermentation progresses.
- Fed-batch systems are useful when catabolite repression likely inhibits the metabolism of the cells and where it is desirable to have limited amounts of substrate in the medium. Measurement of the actual substrate concentration in fed-batch systems is difficult and is therefore estimated on the basis of the changes of measurable factors, such as pH, dissolved oxygen and the partial pressure of waste gases, such as CO 2 . Batch and fed-batch fermentations are common and known in the art.
- Continuous fermentation is an open system where a defined fermentation medium is added continuously to a bioreactor, and an equal amount of conditioned medium is removed simultaneously for processing.
- Continuous fermentation generally maintains the cultures at a constant high density, where cells are primarily in log phase growth.
- Continuous fermentation allows for the modulation of one or more factors that affect cell growth and/or product concentration.
- a limiting nutrient such as the carbon source or nitrogen source
- a number of factors affecting growth can be altered continuously while the cell concentration, measured by media turbidity, is kept constant.
- Continuous systems strive to maintain steady state growth conditions. Thus, cell loss due to medium being drawn off should be balanced against the cell growth rate in the fermentation.
- a transgalactosylating polypeptide produced by a modified host cell may be recovered from the culture medium by conventional procedures including separating the host cells from the medium by centrifugation or filtration, or if necessary, disrupting the cells and removing the supernatant from the cellular fraction and debris.
- the proteinaceous components of the supernatant or filtrate are precipitated by means of a salt, e.g. , ammonium sulfate.
- the precipitated proteins are then solubilized and may be purified by a variety of chromatographic procedures, e.g., ion exchange chromatography, gel filtration.
- the disclosure provides a method for producing a food product by treating a substrate comprising lactose with a transgalactosylating polypeptide or a polypeptide composition thereof as described herein.
- the disclosure provides a method for producing a dairy product by treating a milk-based substrate comprising lactose with a transgalactosylating polypeptide or a polypeptide composition thereof as described herein.
- the substrate comprising lactose is further treated with a hydrolyzing ⁇ -galactosidase.
- the enzyme preparation such as in the form of a food ingredient prepared according to the present disclosure, may be in the form of a solution or as a solid, depending on the use and/or the mode of application and/or the mode of administration.
- the solid form can be either as a dried enzyme powder or as a granulated enzyme.
- an enzyme composition may comprise at least 5%, such as, for example, 10%, 15%, 20%, 25%, 30%, 35%, 40%, 45%, 50% w/w of one or more transgalactosylating polypeptide(s) disclosed herein based on the total amount of polypeptides in the composition.
- This may be evaluated by using the following techniques know to a person skilled in the art.
- the samples to be evaluated are subjected to SDS-PAGE and visualized using a dye appropriate for protein quantification, such as for example the Bio-Rad Criterion system.
- the gel is then scanned using an appropriate densiometic scanner such as for example the Bio-Rad Criterion system and the resulting picture is ensured to be in the dynamic range.
- the total number of polypeptides can be determined by western blotting using a polyclonal antibody with specificity to a ⁇ -galactosidase/lactase polypeptide of SED ID NO: 4, 6, 8, 10, 12, 14, 16, 17, 18 or 26, by methods know to a person skilled in the art.
- composition according to the present disclosure comprises one or more polypeptide(s) selected from the group consisting of a SEQ ID NO: 4, 6, 8, 10, 12, 14, 16, 17, 18 and 26.
- the disclosure provides an enzyme complex preparation comprising the enzyme complex according to the invention, an enzyme carrier and optionally a stabilizer and/or a preservative.
- the enzyme carrier may be selected from the group consisting of glycerol or water.
- the enzyme carrier may not comprise a polyol (e.g ., glycerol, propylene glycol or sorbitol).
- the preparation/composition may comprise a stabilizer.
- the stabilizer may be selected from the group consisting of inorganic salts, polyols, sugars and combinations thereof.
- the stabilizer may be an inorganic salt such as potassium chloride.
- the polyol may be glycerol, propylene glycol, or sorbitol.
- the stabilizer may not be a polyol such as glycerol, propylene glycol, or sorbitol.
- the stabilizer may be a small-molecule carbohydrate, in particular any of several sweet-tasting ones such as glucose, galactose, fructose and saccharose.
- the preparation may comprise a preservative.
- the preservative may be methyl paraben, propyl paraben, benzoate, sorbate or other food approved preservatives or a mixture thereof.
- the methods of the disclosure can be practiced with immobilized enzymes (e.g. an immobilized lactase or other GOS producing enzymes).
- the enzyme can be immobilized on any organic or inorganic support.
- Exemplary inorganic supports include alumina, celite, Dowex-1 -chloride, glass beads and silica gel.
- Exemplary organic supports include DEAE- cellulose, alginate hydrogels or alginate beads or equivalents.
- immobilization of the ⁇ -galactosidase/lactase may be optimized by physical adsorption on to the inorganic support.
- Enzymes used to practice the instant disclosure can be immobilized in different media, including water, Tris-HCI buffer and phosphate buffered solution.
- the enzyme can be immobilized to any type of substrate (e.g. , filters, fibers, columns, beads, colloids, gels, hydrogels, meshes and the like).
- a method for producing a dairy product by treating a milk-based substrate comprising lactose with a polypeptide or a polypeptide composition as described herein is disclosed.
- a method for producing a dairy product by treating a milk-based substrate comprising lactose with a polypeptide having a relative transgalactosylation activity above 60%, such as above 70%, such as above 75% after 15 minutes of reaction is provided.
- the relative transgalactosylation activity may be above 3 after 30 minutes of reaction.
- the relative transgalactosylation activity may be above 6 after 30 minutes of reaction.
- the relative transgalactosylation activity may be above 12 after 30 minutes of reaction.
- a method wherein the treatment with a polypeptide or a polypeptide composition as described herein takes place at an optimal temperature for the activity of the enzyme.
- the polypeptide or the polypeptide composition may be added to the milk-based substrate at a concentration of 0.01-1000 ppm.
- the polypeptide or the polypeptide composition may be added to the milk-based substrate at a concentration of 0.1-100 ppm.
- the polypeptide or the polypeptide composition may be added to the milk- based substrate at a concentration of 1-10 ppm.
- a method further comprising fermenting a substrate such as a dairy product with a microorganism is described.
- the dairy product may be yogurt.
- the treatment with the polypeptide or the polypeptide composition and the microorganism may be performed essentially at the same time.
- the polypeptide or the polypeptide composition and the microorganism may be added to the milk-based substrate essentially at the same time.
- a dairy product comprising a cell or a polypeptide or a polypeptide composition as described herein is disclosed.
- the polypeptide or the polypeptide composition as defined herein may be added in a concentration of 0.01 -1000 ppm.
- a dairy product comprising GOS formed in situ by a polypeptide or a polypeptide composition as defined herein is disclosed. In one example, a dairy product comprising a cell as defined herein is disclosed.
- a dairy product as described herein may be, e.g., skim milk, low fat milk, whole milk, cream, UHT milk, milk having an extended shelf life, a fermented milk product, cheese, yoghurt, butter, dairy spread, butter milk, acidified milk drink, sour cream, whey based drink, ice cream, condensed milk, dulce de leche or a flavoured milk drink.
- a dairy product may be manufactured by any method known in the art.
- a dairy product may additionally comprise non-milk components (e.g ., vegetable components such as vegetable oil, vegetable protein, and/or vegetable carbohydrates). Dairy products may also comprise further additives such as enzymes, flavouring agents, microbial cultures such as probiotic cultures, salts, sweeteners, sugars, acids, fruit, fruit juices, or any other component known in the art as a component of, or additive to, a dairy product.
- one or more milk components and/or milk fractions may account for at least 50% (weight/weight), such as at least 70%, e.g., at least 80%, preferably at least 90%, of the dairy product.
- one or more milk-based substrates having been treated with an enzyme as defined herein having transgalactosylating activity may account for at least 50% (weight/weight), such as at least 70%, e.g. at least 80%, preferably at least 90%, of the dairy product.
- the dairy product may be a dairy product which is not enriched by addition of pre-produced galactooligosaccharides (GOSs).
- GOSs galactooligosaccharides
- the polypeptide-treated milk-based substrate may not be dried before being used as an ingredient in the dairy product.
- the dairy product may be ice cream.
- ice cream may be any kind of ice cream such as full fat ice cream, low fat ice cream, or ice cream based on yoghurt or other fermented milk products. Ice cream may be manufactured by any method known in the art.
- the dairy product may be milk or condensed milk.
- the dairy product may be ultra-high temperature (UHT) milk.
- UHT milk in the context of the present disclosure is milk which has been subjected to a sterilization procedure which is intended to kill all microorganisms, including the bacterial spores.
- UHT treatment includes a heat treatment for 30 seconds at 130°C, or heat treatment for one second at 145°C.
- the dairy product may be ESL milk.
- ESL milk in the present context is milk which has an extended shelf life due to microfiltration and/or heat treatment, and which is able to stay fresh for at least 15 days, preferably for at least 20 days, on the store shelf at 2-5°C.
- the dairy product may be a fermented dairy product (e.g ., yoghurt).
- lactic acid bacteria designates a gram-positive, microaerophilic or anaerobic bacterium, which ferments sugars with the production of acids, including lactic acid as the predominantly produced acid, acetic acid and propionic acid.
- Lactococcus spp. Streptococcus spp., Lactobacillus spp., Leuconostoc spp., Pseudoleuconostoc spp., Pediococcus spp., Brevibacterium spp., Enterococcus spp. and Propionibacterium spp.
- lactic acid producing bacteria belonging to the group of anaerobic bacteria bifidobacteria (i.e., Bifidobacterium spp.), which are frequently used as food cultures alone or in combination with lactic acid bacteria, are generally included in the group of lactic acid bacteria.
- Lactic acid bacteria are normally supplied to the dairy industry either as frozen or freeze- dried cultures for bulk starter propagation or as so-called "Direct Vat Set” (DVS) cultures, intended for direct inoculation into a fermentation vessel or vat for the production of a fermented dairy product. Such cultures are in general referred to as “starter cultures” or “starters”.
- Commonly used starter culture strains of lactic acid bacteria are generally divided into mesophilic organisms having optimum growth temperatures at about 30°C and thermophilic organisms having optimum growth temperatures in the range of about 40°C to about 45°C.
- Typical organisms belonging to the mesophilic group include Lactococcus lactis, Lactococcus lactis subsp. cremoris, Leuconostoc mesenteroides subsp. cremons, Pseudoleuconostoc mesenteroides subsp. cremoris, Pediococcus pentosaceus, Lactococcus lactis, Lactobacillus casei subsp. casei and Lactobacillus paracasei subsp.
- Thermophilic lactic acid bacterial species include as examples Streptococcus thermophilus, Enterococcus faecium, Lactobacillus delbrueckii subsp. lactis, Lactobacillus helveticus, Lactobacillus delbrueckii subsp. bulgaricus and Lactobacillus acidophilus.
- anaerobic bacteria belonging to the genus Bifidobacterium including Bifidobacterium bifidum, Bifidobactenum animalis and Bifidobacterium longum are commonly used as dairy starter cultures and are generally included in the group of lactic acid bacteria. Additionally, species of Propionibacteria are used as dairy starter cultures, in particular in the manufacture of cheese. Additionally, organisms belonging to the Brevibacterium genus are commonly used as food starter cultures.
- microbial starter cultures are fungal cultures, including yeast cultures and cultures of filamentous fungi, which are particularly used in the manufacture of certain types of cheese and beverage.
- fungi include Penicillium roqueforti, Penicillium candidum, Geotrichum candidum, Torula kefir, Saccharomyces kefir and Saccharomyces cerevisiae.
- the microorganism used for fermentation of the milk-based substrate is Lactobacillus casei or a mixture of Streptococcus thermophilus and Lactobacillus delbrueckii subsp. bulgaricus.
- Fermentation processes to be used in a method of the present disclosure are well known and the person of skill in the art will know how to select suitable process conditions, such as temperature, oxygen, amount and characteristics of microorganism, additives such as carbohydrates, flavors, minerals, enzymes, and process time. Obviously, fermentation conditions are selected so as to support the achievement of the present dislcosure.
- the pH of a fermented dairy product of the disclosure may be in the pH range 3.5-6, such as in the pH range 3.5-5, preferably in the pH range 3.8-4.8.
- the disclosure relates to methods of using the polypeptides or the polypeptide compositions or using any one or more of the above mentioned modified host cell types for producing oligosaccharides are provided.
- the oligosaccharides comprise, but are not limited to fructo-oligosaccharides, galactooligosaccharides, isomalto-oligosaccharides, malto-oligosaccharides, lactosucrose and xylooligosaccharides.
- the oligosaccharides may be produced by incubating a modified host cell of the disclosure expressing the polypeptide in a medium that comprises a disaccharide substrate such as for example lactulose, trehalose, rhamnose, maltose, sucrose, lactose, or cellobiose.
- a disaccharide substrate such as for example lactulose, trehalose, rhamnose, maltose, sucrose, lactose, or cellobiose.
- the cells may be part of a product selected from the group consisting of yoghurt, cheese, fermented milk products, dietary supplements, and probiotic comestible products.
- the oligosaccharides can be recovered and subsequently be added to the product of interest before or after its preparation.
- a herein disclosed modified host cell for producing a product selected from the group consisting of yoghurt, cheese, fermented milk product, dietary supplement and probiotic comestible product is described.
- transgalactosylating polypeptide or a polypeptide composition as disclosed herein for producing galactooligosaccharides (GOSs) is described.
- a transgalactosylating polypeptide or a polypeptide composition as disclosed herein or a cell as disclosed herein for producing galactooligosaccharides to be part of a product selected from the group consisting of yoghurt, cheese, fermented dairy products, dietary supplements and probiotic comestible products is described.
- the product is yoghurt, cheese, or a fermented dairy product.
- transgalactosylating polypeptide or a polypeptide composition (or a modified host cell) as disclosed herein, for producing galactooligosaccharides to enhance the growth of Bifidobacterium are described.
- transgalactosylating polypeptide or a polypeptide composition or modified host cell as disclosed herein for producing galactooligosaccharides to enhance the growth of Bifidobacterium in a mixed culture fermentation is described.
- a process for producing a transgalactosylating polypeptide or a polypeptide composition as disclosed herein comprising culturing a modified host cell as disclosed herein in a suitable culture medium under conditions permitting expression of the polypeptide, and recovering the resulting polypeptide from the culture is described.
- a process for producing galactooligosaccharides comprising contacting a polypeptide or a polypeptide composition as disclosed herein or a cell as disclosed herein with a milk-based solution comprising lactose is described.
- Addition of oligosaccharides may enhance growth of either Bifidobacterium alone or of Bifidobacterium in a mixed culture.
- the transgalactosylating polypeptide or the polypeptide composition thereof may be used together with other enzymes such as proteases, such as chymosin or rennin, lipases such as phospholipases, amylases, transferases, and lactases.
- the transgalactosylating polypeptide(s) as disclosed herein may be used together with lactase. This may especially be useful when there is a desire to reduce residual lactose after treatment with the transgalactosylating polypeptide(s) as disclosed herein, especially at low lactose levels.
- the enzyme may be a lactase from a bacterium ( e.g.
- Applicants of the present disclosure discovered a foul off flavor in yoghurt and UHT milk when formulating these dairy products with a ⁇ -galactosidase enzyme produced in a Bacillus host cell. For example, at day one (1) of the addition of the ⁇ -galactosidase enzyme to either a yoghurt product or UHT milk product, one (1) of four (4) people could detect the off flavor in the yoghurt, wherein the off flavor became significantly worse by day five (5).
- the off flavor characterization was consistent with a lipase activity rendering short chain free fatty acids (e.g . butyric acid) in the product.
- the off-flavor could be a lipase contamination of the UFC in the ⁇ -galactosidase production, a lipase contamination during spray drying/blending, or a batch-to-batch variation of a lipase expressed from the host organism ( Bacillus subtilis ).
- the lipase/phospholipase activity detected in these samples indicated that the lipase/phospholipase activity was not a result of cross contamination from a lipase during spray drying, as the lipase/phospholipase activity was present in several independent batches.
- the lipase activity in sample "C” was quantified to 0.41 LIPU/g using the LIPU-K (E117) analysis and correcting for sample blank value.
- the sample could be diluted 160-fold and still detect a positive halo ( see, FIG. 1B ), although the sample only held 0.41 LIPU/g, indicating that detection of as little as 0.0026 LIPU/g in a solution was possible when applying 10 ⁇ L to the plate.
- sample D and E from small scale fermentations show approximately half the lipase level, compared to materials originating from the full scale fermentation sample C. It does indicate that the lipase/esterase level had increased when going into full scale (fermentation) production. Taking the above into consideration, it is not too surprising that sample C from the large scale (fermentation) production shows increased lipase activity relative to samples D and E from the small scale (fermentation) production, as the large scale fermentation of sample C has a higher number of cell doublings ( i.e., generations) than small scale fermentation ( i . e ., samples D and E).
- the most probable explanation for a higher level of (unwanted) lipase side activity is that the activity thereof originates from the Bacillus host cell used to produce the ⁇ -galactosidase enzyme.
- the threshold limit of tasting this off-flavor in yoghurt was initially unknown, whereas the data presented herein indicates that going from 0.11 LIPU/1000 BLU to 0.25 LIPU/1000 BLU shifted the off-flavor from below detection limits to above detection limits by tasting within the first week.
- FIG. 2 , panel B The first part ( FIG. 2 , panel B) was placed on an agar gel ( FIG. 2 , panel A) containing 1% tributyrin, 0.75% lecithin, 0.2 M HEPES buffer (pH 7.4), 0.01M CaCl 2 and phenol red and incubated at 40°C for two (2) hours. The second part was fixed and stained with coomassie ( FIG. 2 , panel C). From the agar gel ( FIG.
- the result of nano-LC-MSMS identification showed an identified para-nitrobenzylesterase ( p -NBE; SEQ ID NO: 2) in the upper band (upper arrow in FIG. 2 , panel C), which is described in the literature as having lipase activity (Ribitsch et al ., 2011).
- the result further indicates that the p -NBE enzyme originates from the Bacillus subtilis host cell ( i.e ., as opposed to cross-contamination).
- a carboxyesterase was identified in the lower band (lower arrow in FIG. 2 , panel C), wherein the identified carboxyesterase has high sequence homology to the p -NBE.
- sequence comparison revealed that the identified carboxyesterase was an artifact of proteolytic cleavage of the para-nitrobenzylesterase.
- the biochemical characteristics of the B. subtilis p-NBE has been described in the literature (Chen et al., 1995; Kaiser et al., 2006; Ribitsch et al. , 2011).
- the enzyme is specific towards short chain p- nitrophenyl esters and triacylglycerols.
- the p -NBE has a pH optimum of 8 and is stimulated by Ca 2+ .
- the lipase/esterase spot plates used in the present disclosure are pH 7.4 and contain Ca 2+ , providing further evidence of why these particular spot plates are very sensitive towards the p -NBE enzyme.
- the p -NBE enzyme is almost inactive at pH 5 ( ⁇ 10% remaining activity), but retains approximately 50% activity at pH 6.5, relative to its pH optimum of 8 (Kaiser et al. , 2006).
- the different pH specifications on the UFC's might explain why more lipase activity is observed in the material B compared to the material A, as the p -NBE is less stable at the low pH.
- the p -NBE should be stable up to 50°C, but will be rapidly and irreversible inactivated at temperatures above 50°C.
- lactase activity was quantified according to a ten (10) minute hydrolysis of a colorless substrate, 2-nitrophelyl ⁇ -D-galactopyranoside (ONPG) to a yellow 2-nitrophenol (ONP) and galactose at 30°C.
- the reaction was stopped with 750 ⁇ L 10% sodium carbonate, and ONP was determined at OD 420 .
- the activity was calculated against a standard curve prepared by dilutions of sample C. Set forth in Table 5 are the ⁇ -galactosidase activities after 53°C heat treatment of the samples.
- the esterase activity is not significantly reduced by the 48°C incubation and one would need to incubate for 129 minutes or more to inactivate the esterase.
- the 53°C incubation is the most effective temperature, having reduced the activity approximately 95 % after just 20 minutes.
- FIG. 6 after 20 minutes of incubation, there is not much difference in recovery between temperatures used (i.e., 48°C, 51°C and 53°C), and further incubation time will only lead to further reduction of lactase activity at all temperatures tested.
- a temperature of 53°C for 20 minutes would be the recommended treatment of the UFC sample A (although longer incubation times may be required for larger volumes).
- the Bacillus subtilis pnbA gene (SEQ ID NO: 1) encoding the para -nitrobenzylesterase (SEQ ID NO: 2) was deleted using the marker-less method described by Janes and Stibitz (2006).
- the construction of the integration plasmid pKSV-I-Sce-Km was performed as follows.
- I-SceI-1 cgatTAGGGATAACAGGGTAATat; SEQ ID NO: 19, bold letters with underline are a homologous sequence of I-SceI restriction enzyme site
- I-SceI-2 cgatATTACCCTGTTATCCCTAat; SEQ ID NO: 20
- the annealed fragment was phosphorylated with T4 polynucleotide kinase (New England BioLabs) and was then ligated with the ClaI site of pKSV7 (Smith and Youngman, 1992).
- the plasmid was digested with NcoI and MfeI, and was blunted with T4 DNA polymerase (New England BioLabs).
- the fragment containing repF and cop-6 had been separated from the chloramphenicol resistance gene fragment by agarose gel electrophoresis, and purified with a gel extraction kit (Qiagen), then self-ligated to originate the pKS vector.
- the pKS vector was digested with the restriction endonuclease HindIII and ligated to the kanamacyn resistant gene derived from the plasmid pDG780 (Guérout-Fleury et al., 1995) after digestion with HindIII restriction endonuclease, wherein the resulting plasmid is "pKSV-I-Sce Km".
- the loci upstream and downstream the pnbA gene were amplified by PCR from B. subtilis 168 genomic DNA, using the following primers: Primer No. 981: 5'-AACCAGCACTAGTGTCGACGCCTGGTAGGTCG-3' (SEQ ID NO: 21); Primer No. 984: 5'-GCACCAATGTATCCTGTTTTCCCCATATCGTTAGCCCTTTAACCGATCATCATC-3' (SEQ ID NO: 22); Primer No. 985: 5'-ATATGGATCCGTTCTACTAGACATTTATGAAGTACAG-3' (SEQ ID NO: 23) and Primer No. 983: 5'-GATGATGATCGGTTAAAGGGCTAACGATATGGGGAAAACAGG -3' (SEQ ID NO: 24).
- the two PCR products were assembled by fusion PCR using Primer No. 981: 5'-AACCAGCAC TAGTGTCGACGCCTGGTAGGCG-3' (SEQ ID NO: 21) and Primer No. 985: 5'-ATATGGATCCGT TCTACTAGACATTTATGAAGTACAG-3' (SEQ ID NO: 23).
- the amplicon was digested with the restrictions sites SpeI and BamHI, and ligated to the pKSV-I-Sce-Km vector linearized with the restriction enzymes XbaI and BamHI, wherein the resulting vector was named pKSV-ISce-pnbA.
- the pKSV-ISce-pnbA vector was transformed and integrated into the genome of a parental B . subtilis host cell.
- a second vector, called pKBJ233 (Janes and Stibitz, 2006), containing the expression construct for the restriction enzyme I-Sce was used to transform the parental B. subtilis (pksV-ISce-pnbA) host cell.
- the strain was grown for 72 hours by renewing the media every 12 hours, then re-isolated on Luria agar plates.
- the kanamycin sensitive clones were selected and tested by PCR for the deletion of the pnbA gene.
- the resulting B. subtilis daughter cell i.e., comprising a deleted pnbA gene
- CB103 The resulting B. subtilis daughter cell
- the B. subtilis gene encoding the identified and unwanted p -NBE enzyme activity was deleted in the B. subtilis ( ⁇ -galactosidase and/or lactase producing) host cell of the instant disclosure.
- the resulting p -NBE deleted B. subtilis host cell described in Example 2 was used for fermentation of the ⁇ -galactosidase.
- the deletion (knockingout) of particular a gene presents certain risks if the deleted gene in question is either essential to the host cell or if the host cell compensates by expressing another enzyme with similar characteristics.
- the gene encoding the p -NBE enzyme is not essential to the B. subtilis host cell, and as such, the UFC material resulting from the fermentation of the p -NBE deleted B. subtilis host cell was therefore tested for esterase activity by the spot plate analysis.
- sample C i.e. , comprising the p -NBE side-activity
- new p -NBE free material i.e ., produced from the B. subtilis ⁇ p -NBE host cell
- FIG. 11 Yoghurt
- FIG. 12 UHT milk
- the new UFC material is comparable to the control (i.e., FIG. 11 and 12 ; Reference, no enzyme added) and as such, the new UFC material does not result in off-flavor in the specified applications.
- FIG. 11 and FIG. 12 clearly show that the esterase containing material (Old strain) has higher levels of free fatty acids and ketones than the other samples ( i.e., New strain), wherein the 2-heptanone in the UHT milk contributes significantly to the off-flavor.
- the deletion of the gene encoding the p -NBE enzyme (SEQ ID NO: 2) in the B. subtilis host cell completely eliminated the off-flavor caused by the p -NBE enzymatic side activity present in the original (parental) B. subtilis host cell, which p -NBE activity has been eliminated in the modified (daughter) B. subtilis host cell.
Landscapes
- Life Sciences & Earth Sciences (AREA)
- Chemical & Material Sciences (AREA)
- Health & Medical Sciences (AREA)
- Engineering & Computer Science (AREA)
- Organic Chemistry (AREA)
- Genetics & Genomics (AREA)
- Zoology (AREA)
- Wood Science & Technology (AREA)
- Bioinformatics & Cheminformatics (AREA)
- Microbiology (AREA)
- General Engineering & Computer Science (AREA)
- Biotechnology (AREA)
- Biochemistry (AREA)
- General Health & Medical Sciences (AREA)
- Biomedical Technology (AREA)
- Molecular Biology (AREA)
- Medicinal Chemistry (AREA)
- Food Science & Technology (AREA)
- Polymers & Plastics (AREA)
- General Chemical & Material Sciences (AREA)
- Chemical Kinetics & Catalysis (AREA)
- Proteomics, Peptides & Aminoacids (AREA)
- Biophysics (AREA)
- Virology (AREA)
- Tropical Medicine & Parasitology (AREA)
- Plant Pathology (AREA)
- Physics & Mathematics (AREA)
- Enzymes And Modification Thereof (AREA)
- Micro-Organisms Or Cultivation Processes Thereof (AREA)
- Dairy Products (AREA)
Applications Claiming Priority (2)
| Application Number | Priority Date | Filing Date | Title |
|---|---|---|---|
| US201762483239P | 2017-04-07 | 2017-04-07 | |
| PCT/US2018/026170 WO2018187524A1 (en) | 2017-04-07 | 2018-04-05 | BACILLUS HOST CELLS PRODUCING β-GALACTOSIDASES AND LACTASES IN THE ABSENCE OF P-NITROBENZYLESTERASE SIDE ACTIVITY |
Publications (2)
| Publication Number | Publication Date |
|---|---|
| EP3607097A1 EP3607097A1 (en) | 2020-02-12 |
| EP3607097B1 true EP3607097B1 (en) | 2023-06-21 |
Family
ID=62067805
Family Applications (1)
| Application Number | Title | Priority Date | Filing Date |
|---|---|---|---|
| EP18720841.8A Active EP3607097B1 (en) | 2017-04-07 | 2018-04-05 | Bacillus host cells producing beta-galactosidases and lactases in the absence of p-nitrobenzylesterase side activity |
Country Status (7)
| Country | Link |
|---|---|
| US (1) | US11479763B2 (da) |
| EP (1) | EP3607097B1 (da) |
| JP (1) | JP7065114B2 (da) |
| KR (1) | KR102533803B1 (da) |
| DK (1) | DK3607097T3 (da) |
| FI (1) | FI3607097T3 (da) |
| WO (1) | WO2018187524A1 (da) |
Families Citing this family (13)
| Publication number | Priority date | Publication date | Assignee | Title |
|---|---|---|---|---|
| CN110678479A (zh) | 2017-04-11 | 2020-01-10 | 科·汉森有限公司 | 性能改善的乳糖酶 |
| US12435326B2 (en) * | 2017-04-11 | 2025-10-07 | Kerry Group Services International Ltd | Lactase enzymes with improved properties |
| ES3057273T3 (en) | 2017-04-11 | 2026-02-27 | Kerry Group Services Int Ltd | Lactase enzymes with improved properties |
| FI3609909T3 (fi) | 2017-04-11 | 2025-09-03 | Kerry Group Services Int Ltd | Laktaasientsyymit, joilla on parannettu aktiivisuus matalissa lämpötiloissa |
| BR112021007244A2 (pt) * | 2018-10-17 | 2021-08-10 | Chr. Hansen A/S | enzimas lactase com propriedades melhoradas em ph ácido |
| CN113301812A (zh) * | 2018-10-17 | 2021-08-24 | 完美日股份有限公司 | 用于食物产品的重组组分和组合物 |
| BR112021016954A2 (pt) * | 2019-02-28 | 2021-11-23 | Dupont Nutrition Biosci Aps | Método para reduzir lactose em temperaturas altas |
| AU2020375621A1 (en) | 2019-10-28 | 2022-04-28 | Danisco Us Inc | Methods and compositions for remediating cyanuric acid in aqueous liquids |
| WO2021086606A1 (en) | 2019-10-28 | 2021-05-06 | Danisco Us Inc | Microbial host cells for the production of heterologous cyanuric acid hydrolases and biuret hydrolases |
| CN111411117B (zh) * | 2020-04-27 | 2020-12-01 | 江南大学 | 一种耐热β-葡萄糖苷酶在低聚龙胆糖制备中的应用 |
| CN111849940B (zh) * | 2020-07-28 | 2022-03-25 | 量子高科(广东)生物有限公司 | 一种β-半乳糖苷酶的制备方法及其应用 |
| WO2024101286A1 (ja) * | 2022-11-11 | 2024-05-16 | 雪印メグミルク株式会社 | N-アセチルラクトサミンの製造方法及びn-アセチルラクトサミン含有組成物 |
| CN120005857B (zh) * | 2023-11-07 | 2025-10-17 | 中国农业大学 | 米曲霉β-半乳糖苷酶突变体的高效表达及在乳品中的应用 |
Family Cites Families (35)
| Publication number | Priority date | Publication date | Assignee | Title |
|---|---|---|---|---|
| JP2930370B2 (ja) | 1990-05-25 | 1999-08-03 | 雪印乳業株式会社 | ガラクトオリゴ糖類含有脱脂粉乳の製造方法 |
| WO1996000786A1 (en) * | 1994-06-29 | 1996-01-11 | Genencor International, Inc. | INCREASED PRODUCTION OF β-GALACTOSIDASE IN ASPERGILLUS ORYZAE |
| WO1999050399A2 (en) | 1998-04-01 | 1999-10-07 | Danisco A/S | Non-maltogenic exoamylases and their use in retarding retrogradation of starch |
| US5945325A (en) * | 1998-04-20 | 1999-08-31 | California Institute Of Technology | Thermally stable para-nitrobenzyl esterases |
| FR2778921B1 (fr) * | 1998-05-22 | 2001-05-11 | Gervais Danone Sa | Souches mutantes de lactobacillus bulgaricus depourvues d'activite beta-galactosidase |
| US6509185B1 (en) | 2000-01-07 | 2003-01-21 | Genencor International, Inc. | Mutant aprE promotor |
| KR20080045766A (ko) | 2000-05-26 | 2008-05-23 | 아를라 푸즈 에이엠비에이 | 비피도박테륨에서 단리한 베타-갈락토시다제 |
| WO2002014490A2 (en) | 2000-08-11 | 2002-02-21 | Genencor International, Inc. | Bacillus transformation, transformants and mutant libraries |
| DK1495128T3 (da) | 2002-03-29 | 2014-08-11 | Genencor Int | Forstærket proteinekspression i Bacillus |
| EP1499346B1 (en) | 2002-04-09 | 2008-01-02 | The Curators Of The University Of Missouri | Treatment of type 1 diabetes before and after expression of predisposition markers |
| JP2006513692A (ja) | 2002-04-22 | 2006-04-27 | ジェネンコー・インターナショナル・インク | 様々なレベルの遺伝子発現を生じる修飾プロモーターを作成する方法 |
| DK1654355T3 (da) | 2003-06-13 | 2010-08-09 | Danisco | Pseudomonas polypeptidvarianter med ikke-maltogen exoamylaseaktivitet og deres anvendelse til fremstilling af fødevarer |
| CA2536376A1 (en) | 2003-07-07 | 2005-01-27 | Genencor International, Inc. | Exo-specific amylase polypeptides, nucleic acids encoding those polypeptides and uses thereof |
| US8143048B2 (en) | 2003-07-07 | 2012-03-27 | Danisco A/S | Exo-specific amylase polypeptides, nucleic acids encoding those polypeptides and uses thereof |
| EP1644542B1 (en) | 2003-07-15 | 2011-11-02 | Mintek | Oxidative leach process |
| WO2005026356A1 (en) | 2003-09-12 | 2005-03-24 | Commonwealth Scientific And Industrial Research Organisation | Modified gene-silencing nucleic acid molecules and uses thereof |
| US20060018997A1 (en) | 2004-07-07 | 2006-01-26 | Kragh Karsten M | Polypeptide |
| US20060008890A1 (en) | 2004-07-07 | 2006-01-12 | Kragh Karsten M | Polypeptide |
| US20060008888A1 (en) | 2004-07-07 | 2006-01-12 | Kragh Karsten M | Polypeptide |
| US20060073583A1 (en) | 2004-09-22 | 2006-04-06 | Kragh Karsten M | Polypeptide |
| WO2006091231A2 (en) | 2004-07-21 | 2006-08-31 | Ambrx, Inc. | Biosynthetic polypeptides utilizing non-naturally encoded amino acids |
| MX2008000374A (es) | 2005-07-07 | 2008-03-07 | Danisco | Amilasa modificada de pseudomonas saccharophilia. |
| FI20065593A7 (fi) | 2006-09-26 | 2008-03-27 | Valio Oy | Menetelmä galakto-oligosakkarideja sisältävien tuotteiden valmistamiseksi ja niiden käyttö |
| US20100285175A1 (en) | 2007-12-03 | 2010-11-11 | Novozymes A/S | Method for Producing a Dairy Product |
| WO2011120993A1 (en) | 2010-03-29 | 2011-10-06 | Danisco A/S | Polypeptides having transgalactosylating activity |
| NZ607149A (en) | 2010-07-19 | 2014-12-24 | Arla Foods Amba | Galacto-oligosaccharide-containing composition and a method of producing it |
| TWI527522B (zh) | 2010-08-13 | 2016-04-01 | 愛之味股份有限公司 | 製備富含半乳寡醣及低乳糖之易吸收乳製品之方法及以該方法製備之機能性乳製品 |
| US9029107B2 (en) * | 2010-08-31 | 2015-05-12 | Api Corporation | Hydrolase protein |
| ES2397334B1 (es) * | 2011-06-24 | 2014-06-06 | Queizúar, S.L. | Cepa de levadura kluyveromyces lactis y procedimiento de obtención de azúcares, etanol, beta-galactosidasa y biomasa. |
| WO2013086219A1 (en) | 2011-12-09 | 2013-06-13 | Danisco Us Inc. | Ribosomal promotors from b. subtilis for protein production in microorganisms |
| MX384628B (es) * | 2012-06-08 | 2025-03-14 | Int N&H Denmark Aps | Polipéptidos que tienen actividad de transgalactosilación. |
| EP3446569A1 (en) * | 2013-12-11 | 2019-02-27 | DuPont Nutrition Biosciences ApS | A method for preparing a dairy product having a stable content of galacto-oligosaccharide(s) |
| MX375778B (es) | 2014-01-14 | 2025-03-07 | Dsm Ip Assets Bv | Variantes mejoradas de enzimas. |
| EP3915384A1 (en) * | 2014-11-07 | 2021-12-01 | DuPont Nutrition Biosciences ApS | Recombinant host cell expressing beta-galactosidase and/or transgalactosylating activity deficient in cellulase |
| GB201419900D0 (en) | 2014-11-07 | 2014-12-24 | Dupont Nutrition Biosci Aps | Method |
-
2018
- 2018-04-05 DK DK18720841.8T patent/DK3607097T3/da active
- 2018-04-05 JP JP2019555016A patent/JP7065114B2/ja active Active
- 2018-04-05 WO PCT/US2018/026170 patent/WO2018187524A1/en not_active Ceased
- 2018-04-05 EP EP18720841.8A patent/EP3607097B1/en active Active
- 2018-04-05 KR KR1020197031755A patent/KR102533803B1/ko active Active
- 2018-04-05 US US16/603,100 patent/US11479763B2/en active Active
- 2018-04-05 FI FIEP18720841.8T patent/FI3607097T3/fi active
Also Published As
| Publication number | Publication date |
|---|---|
| JP7065114B2 (ja) | 2022-05-11 |
| DK3607097T3 (da) | 2023-09-18 |
| EP3607097A1 (en) | 2020-02-12 |
| KR102533803B1 (ko) | 2023-05-18 |
| US20200123519A1 (en) | 2020-04-23 |
| KR20190138651A (ko) | 2019-12-13 |
| US11479763B2 (en) | 2022-10-25 |
| JP2020516254A (ja) | 2020-06-11 |
| FI3607097T3 (fi) | 2023-09-11 |
| WO2018187524A1 (en) | 2018-10-11 |
Similar Documents
| Publication | Publication Date | Title |
|---|---|---|
| EP3607097B1 (en) | Bacillus host cells producing beta-galactosidases and lactases in the absence of p-nitrobenzylesterase side activity | |
| EP3473714B1 (en) | Polypeptides having transgalactosylating activity | |
| EP3568024B1 (en) | Process for producing a fermented milk product | |
| US12215367B2 (en) | Lactase enzymes with improved properties | |
| US20220132878A1 (en) | Method for reducing lactose at high temperatures | |
| EP3609908B1 (en) | Lactase enzymes with improved properties | |
| BRPI0811492B1 (pt) | Method for producing an acidified dairy drink, acidified milk drink, and polyepeptide isolated with acidity desamidase | |
| US12435326B2 (en) | Lactase enzymes with improved properties | |
| EP3609909B1 (en) | Lactase enzymes with improved activity at low temperatures | |
| EP3392268B1 (en) | Polypeptides having transgalactosylating activity | |
| EP3214942B1 (en) | Recombinant host cell expressing beta-galactosidase and/or transgalactosylating activity deficient in mannanase, cellulase and pectinase. | |
| US20250324990A1 (en) | Lactase enzymes with improved activity at low temperatures |
Legal Events
| Date | Code | Title | Description |
|---|---|---|---|
| STAA | Information on the status of an ep patent application or granted ep patent |
Free format text: STATUS: UNKNOWN |
|
| STAA | Information on the status of an ep patent application or granted ep patent |
Free format text: STATUS: THE INTERNATIONAL PUBLICATION HAS BEEN MADE |
|
| PUAI | Public reference made under article 153(3) epc to a published international application that has entered the european phase |
Free format text: ORIGINAL CODE: 0009012 |
|
| STAA | Information on the status of an ep patent application or granted ep patent |
Free format text: STATUS: REQUEST FOR EXAMINATION WAS MADE |
|
| 17P | Request for examination filed |
Effective date: 20190920 |
|
| AK | Designated contracting states |
Kind code of ref document: A1 Designated state(s): AL AT BE BG CH CY CZ DE DK EE ES FI FR GB GR HR HU IE IS IT LI LT LU LV MC MK MT NL NO PL PT RO RS SE SI SK SM TR |
|
| AX | Request for extension of the european patent |
Extension state: BA ME |
|
| DAV | Request for validation of the european patent (deleted) | ||
| DAX | Request for extension of the european patent (deleted) | ||
| STAA | Information on the status of an ep patent application or granted ep patent |
Free format text: STATUS: EXAMINATION IS IN PROGRESS |
|
| 17Q | First examination report despatched |
Effective date: 20210902 |
|
| RAP1 | Party data changed (applicant data changed or rights of an application transferred) |
Owner name: DUPONT NUTRITION BIOSCIENCES APS |
|
| GRAP | Despatch of communication of intention to grant a patent |
Free format text: ORIGINAL CODE: EPIDOSNIGR1 |
|
| STAA | Information on the status of an ep patent application or granted ep patent |
Free format text: STATUS: GRANT OF PATENT IS INTENDED |
|
| INTG | Intention to grant announced |
Effective date: 20230105 |
|
| GRAS | Grant fee paid |
Free format text: ORIGINAL CODE: EPIDOSNIGR3 |
|
| GRAA | (expected) grant |
Free format text: ORIGINAL CODE: 0009210 |
|
| STAA | Information on the status of an ep patent application or granted ep patent |
Free format text: STATUS: THE PATENT HAS BEEN GRANTED |
|
| P01 | Opt-out of the competence of the unified patent court (upc) registered |
Effective date: 20230511 |
|
| AK | Designated contracting states |
Kind code of ref document: B1 Designated state(s): AL AT BE BG CH CY CZ DE DK EE ES FI FR GB GR HR HU IE IS IT LI LT LU LV MC MK MT NL NO PL PT RO RS SE SI SK SM TR |
|
| REG | Reference to a national code |
Ref country code: CH Ref legal event code: EP |
|
| REG | Reference to a national code |
Ref country code: DE Ref legal event code: R096 Ref document number: 602018052086 Country of ref document: DE |
|
| REG | Reference to a national code |
Ref country code: AT Ref legal event code: REF Ref document number: 1580930 Country of ref document: AT Kind code of ref document: T Effective date: 20230715 |
|
| REG | Reference to a national code |
Ref country code: IE Ref legal event code: FG4D |
|
| REG | Reference to a national code |
Ref country code: FI Ref legal event code: FGE |
|
| REG | Reference to a national code |
Ref country code: DK Ref legal event code: T3 Effective date: 20230912 |
|
| REG | Reference to a national code |
Ref country code: NL Ref legal event code: FP |
|
| REG | Reference to a national code |
Ref country code: LT Ref legal event code: MG9D |
|
| PG25 | Lapsed in a contracting state [announced via postgrant information from national office to epo] |
Ref country code: SE Free format text: LAPSE BECAUSE OF FAILURE TO SUBMIT A TRANSLATION OF THE DESCRIPTION OR TO PAY THE FEE WITHIN THE PRESCRIBED TIME-LIMIT Effective date: 20230621 Ref country code: NO Free format text: LAPSE BECAUSE OF FAILURE TO SUBMIT A TRANSLATION OF THE DESCRIPTION OR TO PAY THE FEE WITHIN THE PRESCRIBED TIME-LIMIT Effective date: 20230921 |
|
| REG | Reference to a national code |
Ref country code: AT Ref legal event code: MK05 Ref document number: 1580930 Country of ref document: AT Kind code of ref document: T Effective date: 20230621 |
|
| PG25 | Lapsed in a contracting state [announced via postgrant information from national office to epo] |
Ref country code: RS Free format text: LAPSE BECAUSE OF FAILURE TO SUBMIT A TRANSLATION OF THE DESCRIPTION OR TO PAY THE FEE WITHIN THE PRESCRIBED TIME-LIMIT Effective date: 20230621 Ref country code: LV Free format text: LAPSE BECAUSE OF FAILURE TO SUBMIT A TRANSLATION OF THE DESCRIPTION OR TO PAY THE FEE WITHIN THE PRESCRIBED TIME-LIMIT Effective date: 20230621 Ref country code: LT Free format text: LAPSE BECAUSE OF FAILURE TO SUBMIT A TRANSLATION OF THE DESCRIPTION OR TO PAY THE FEE WITHIN THE PRESCRIBED TIME-LIMIT Effective date: 20230621 Ref country code: HR Free format text: LAPSE BECAUSE OF FAILURE TO SUBMIT A TRANSLATION OF THE DESCRIPTION OR TO PAY THE FEE WITHIN THE PRESCRIBED TIME-LIMIT Effective date: 20230621 Ref country code: GR Free format text: LAPSE BECAUSE OF FAILURE TO SUBMIT A TRANSLATION OF THE DESCRIPTION OR TO PAY THE FEE WITHIN THE PRESCRIBED TIME-LIMIT Effective date: 20230922 |
|
| PG25 | Lapsed in a contracting state [announced via postgrant information from national office to epo] |
Ref country code: SK Free format text: LAPSE BECAUSE OF FAILURE TO SUBMIT A TRANSLATION OF THE DESCRIPTION OR TO PAY THE FEE WITHIN THE PRESCRIBED TIME-LIMIT Effective date: 20230621 |
|
| PG25 | Lapsed in a contracting state [announced via postgrant information from national office to epo] |
Ref country code: ES Free format text: LAPSE BECAUSE OF FAILURE TO SUBMIT A TRANSLATION OF THE DESCRIPTION OR TO PAY THE FEE WITHIN THE PRESCRIBED TIME-LIMIT Effective date: 20230621 |
|
| PG25 | Lapsed in a contracting state [announced via postgrant information from national office to epo] |
Ref country code: IS Free format text: LAPSE BECAUSE OF FAILURE TO SUBMIT A TRANSLATION OF THE DESCRIPTION OR TO PAY THE FEE WITHIN THE PRESCRIBED TIME-LIMIT Effective date: 20231021 |
|
| PG25 | Lapsed in a contracting state [announced via postgrant information from national office to epo] |
Ref country code: SM Free format text: LAPSE BECAUSE OF FAILURE TO SUBMIT A TRANSLATION OF THE DESCRIPTION OR TO PAY THE FEE WITHIN THE PRESCRIBED TIME-LIMIT Effective date: 20230621 Ref country code: SK Free format text: LAPSE BECAUSE OF FAILURE TO SUBMIT A TRANSLATION OF THE DESCRIPTION OR TO PAY THE FEE WITHIN THE PRESCRIBED TIME-LIMIT Effective date: 20230621 Ref country code: RO Free format text: LAPSE BECAUSE OF FAILURE TO SUBMIT A TRANSLATION OF THE DESCRIPTION OR TO PAY THE FEE WITHIN THE PRESCRIBED TIME-LIMIT Effective date: 20230621 Ref country code: PT Free format text: LAPSE BECAUSE OF FAILURE TO SUBMIT A TRANSLATION OF THE DESCRIPTION OR TO PAY THE FEE WITHIN THE PRESCRIBED TIME-LIMIT Effective date: 20231023 Ref country code: IS Free format text: LAPSE BECAUSE OF FAILURE TO SUBMIT A TRANSLATION OF THE DESCRIPTION OR TO PAY THE FEE WITHIN THE PRESCRIBED TIME-LIMIT Effective date: 20231021 Ref country code: ES Free format text: LAPSE BECAUSE OF FAILURE TO SUBMIT A TRANSLATION OF THE DESCRIPTION OR TO PAY THE FEE WITHIN THE PRESCRIBED TIME-LIMIT Effective date: 20230621 Ref country code: EE Free format text: LAPSE BECAUSE OF FAILURE TO SUBMIT A TRANSLATION OF THE DESCRIPTION OR TO PAY THE FEE WITHIN THE PRESCRIBED TIME-LIMIT Effective date: 20230621 Ref country code: CZ Free format text: LAPSE BECAUSE OF FAILURE TO SUBMIT A TRANSLATION OF THE DESCRIPTION OR TO PAY THE FEE WITHIN THE PRESCRIBED TIME-LIMIT Effective date: 20230621 Ref country code: AT Free format text: LAPSE BECAUSE OF FAILURE TO SUBMIT A TRANSLATION OF THE DESCRIPTION OR TO PAY THE FEE WITHIN THE PRESCRIBED TIME-LIMIT Effective date: 20230621 |
|
| PG25 | Lapsed in a contracting state [announced via postgrant information from national office to epo] |
Ref country code: PL Free format text: LAPSE BECAUSE OF FAILURE TO SUBMIT A TRANSLATION OF THE DESCRIPTION OR TO PAY THE FEE WITHIN THE PRESCRIBED TIME-LIMIT Effective date: 20230621 |
|
| REG | Reference to a national code |
Ref country code: DE Ref legal event code: R097 Ref document number: 602018052086 Country of ref document: DE |
|
| PLBE | No opposition filed within time limit |
Free format text: ORIGINAL CODE: 0009261 |
|
| STAA | Information on the status of an ep patent application or granted ep patent |
Free format text: STATUS: NO OPPOSITION FILED WITHIN TIME LIMIT |
|
| PG25 | Lapsed in a contracting state [announced via postgrant information from national office to epo] |
Ref country code: SI Free format text: LAPSE BECAUSE OF FAILURE TO SUBMIT A TRANSLATION OF THE DESCRIPTION OR TO PAY THE FEE WITHIN THE PRESCRIBED TIME-LIMIT Effective date: 20230621 |
|
| 26N | No opposition filed |
Effective date: 20240322 |
|
| PG25 | Lapsed in a contracting state [announced via postgrant information from national office to epo] |
Ref country code: SI Free format text: LAPSE BECAUSE OF FAILURE TO SUBMIT A TRANSLATION OF THE DESCRIPTION OR TO PAY THE FEE WITHIN THE PRESCRIBED TIME-LIMIT Effective date: 20230621 Ref country code: IT Free format text: LAPSE BECAUSE OF FAILURE TO SUBMIT A TRANSLATION OF THE DESCRIPTION OR TO PAY THE FEE WITHIN THE PRESCRIBED TIME-LIMIT Effective date: 20230621 |
|
| REG | Reference to a national code |
Ref country code: NL Ref legal event code: HC Owner name: INTERNATIONAL N&H DENMARK APS; DK Free format text: DETAILS ASSIGNMENT: CHANGE OF OWNER(S), CHANGE OF OWNER(S) NAME; FORMER OWNER NAME: DUPONT NUTRITION BIOSCIENCES APS Effective date: 20240603 |
|
| PG25 | Lapsed in a contracting state [announced via postgrant information from national office to epo] |
Ref country code: BG Free format text: LAPSE BECAUSE OF FAILURE TO SUBMIT A TRANSLATION OF THE DESCRIPTION OR TO PAY THE FEE WITHIN THE PRESCRIBED TIME-LIMIT Effective date: 20230621 |
|
| PG25 | Lapsed in a contracting state [announced via postgrant information from national office to epo] |
Ref country code: MC Free format text: LAPSE BECAUSE OF FAILURE TO SUBMIT A TRANSLATION OF THE DESCRIPTION OR TO PAY THE FEE WITHIN THE PRESCRIBED TIME-LIMIT Effective date: 20230621 |
|
| PG25 | Lapsed in a contracting state [announced via postgrant information from national office to epo] |
Ref country code: MC Free format text: LAPSE BECAUSE OF FAILURE TO SUBMIT A TRANSLATION OF THE DESCRIPTION OR TO PAY THE FEE WITHIN THE PRESCRIBED TIME-LIMIT Effective date: 20230621 Ref country code: BG Free format text: LAPSE BECAUSE OF FAILURE TO SUBMIT A TRANSLATION OF THE DESCRIPTION OR TO PAY THE FEE WITHIN THE PRESCRIBED TIME-LIMIT Effective date: 20230621 |
|
| REG | Reference to a national code |
Ref country code: CH Ref legal event code: PL |
|
| REG | Reference to a national code |
Ref country code: BE Ref legal event code: HC Owner name: INTERNATIONAL N&H DENMARK APS; DK Free format text: DETAILS ASSIGNMENT: CHANGE OF OWNER(S), CHANGE OF OWNER(S) NAME; FORMER OWNER NAME: DUPONT NUTRITION BIOSCIENCES APS Effective date: 20240808 |
|
| PG25 | Lapsed in a contracting state [announced via postgrant information from national office to epo] |
Ref country code: LU Free format text: LAPSE BECAUSE OF NON-PAYMENT OF DUE FEES Effective date: 20240405 |
|
| GBPC | Gb: european patent ceased through non-payment of renewal fee |
Effective date: 20240405 |
|
| PG25 | Lapsed in a contracting state [announced via postgrant information from national office to epo] |
Ref country code: LU Free format text: LAPSE BECAUSE OF NON-PAYMENT OF DUE FEES Effective date: 20240405 |
|
| PG25 | Lapsed in a contracting state [announced via postgrant information from national office to epo] |
Ref country code: GB Free format text: LAPSE BECAUSE OF NON-PAYMENT OF DUE FEES Effective date: 20240405 |
|
| PG25 | Lapsed in a contracting state [announced via postgrant information from national office to epo] |
Ref country code: FR Free format text: LAPSE BECAUSE OF NON-PAYMENT OF DUE FEES Effective date: 20240430 |
|
| PG25 | Lapsed in a contracting state [announced via postgrant information from national office to epo] |
Ref country code: GB Free format text: LAPSE BECAUSE OF NON-PAYMENT OF DUE FEES Effective date: 20240405 Ref country code: FR Free format text: LAPSE BECAUSE OF NON-PAYMENT OF DUE FEES Effective date: 20240430 Ref country code: CH Free format text: LAPSE BECAUSE OF NON-PAYMENT OF DUE FEES Effective date: 20240430 |
|
| REG | Reference to a national code |
Ref country code: DE Ref legal event code: R081 Ref document number: 602018052086 Country of ref document: DE Owner name: INTERNATIONAL N&H DENMARK APS, DK Free format text: FORMER OWNER: DUPONT NUTRITION BIOSCIENCES APS, KONGENS LYNGBY, DK Ref country code: DE Ref legal event code: R081 Ref document number: 602018052086 Country of ref document: DE Owner name: INTERNATIONAL N&H DENMARK APS, DK Free format text: FORMER OWNER: DUPONT NUTRITION BIOSCIENCES APS, KOEPENHAVEN, DK |
|
| PG25 | Lapsed in a contracting state [announced via postgrant information from national office to epo] |
Ref country code: IE Free format text: LAPSE BECAUSE OF NON-PAYMENT OF DUE FEES Effective date: 20240405 |
|
| PGFP | Annual fee paid to national office [announced via postgrant information from national office to epo] |
Ref country code: FI Payment date: 20250421 Year of fee payment: 8 |
|
| PGFP | Annual fee paid to national office [announced via postgrant information from national office to epo] |
Ref country code: DE Payment date: 20250305 Year of fee payment: 8 |
|
| PGFP | Annual fee paid to national office [announced via postgrant information from national office to epo] |
Ref country code: DK Payment date: 20250411 Year of fee payment: 8 |
|
| PG25 | Lapsed in a contracting state [announced via postgrant information from national office to epo] |
Ref country code: CY Free format text: LAPSE BECAUSE OF FAILURE TO SUBMIT A TRANSLATION OF THE DESCRIPTION OR TO PAY THE FEE WITHIN THE PRESCRIBED TIME-LIMIT; INVALID AB INITIO Effective date: 20180405 |
|
| PG25 | Lapsed in a contracting state [announced via postgrant information from national office to epo] |
Ref country code: HU Free format text: LAPSE BECAUSE OF FAILURE TO SUBMIT A TRANSLATION OF THE DESCRIPTION OR TO PAY THE FEE WITHIN THE PRESCRIBED TIME-LIMIT; INVALID AB INITIO Effective date: 20180405 |
|
| PG25 | Lapsed in a contracting state [announced via postgrant information from national office to epo] |
Ref country code: TR Free format text: LAPSE BECAUSE OF FAILURE TO SUBMIT A TRANSLATION OF THE DESCRIPTION OR TO PAY THE FEE WITHIN THE PRESCRIBED TIME-LIMIT Effective date: 20230621 |
|
| PGFP | Annual fee paid to national office [announced via postgrant information from national office to epo] |
Ref country code: BE Payment date: 20260317 Year of fee payment: 9 |
|
| PGFP | Annual fee paid to national office [announced via postgrant information from national office to epo] |
Ref country code: NL Payment date: 20260317 Year of fee payment: 9 |